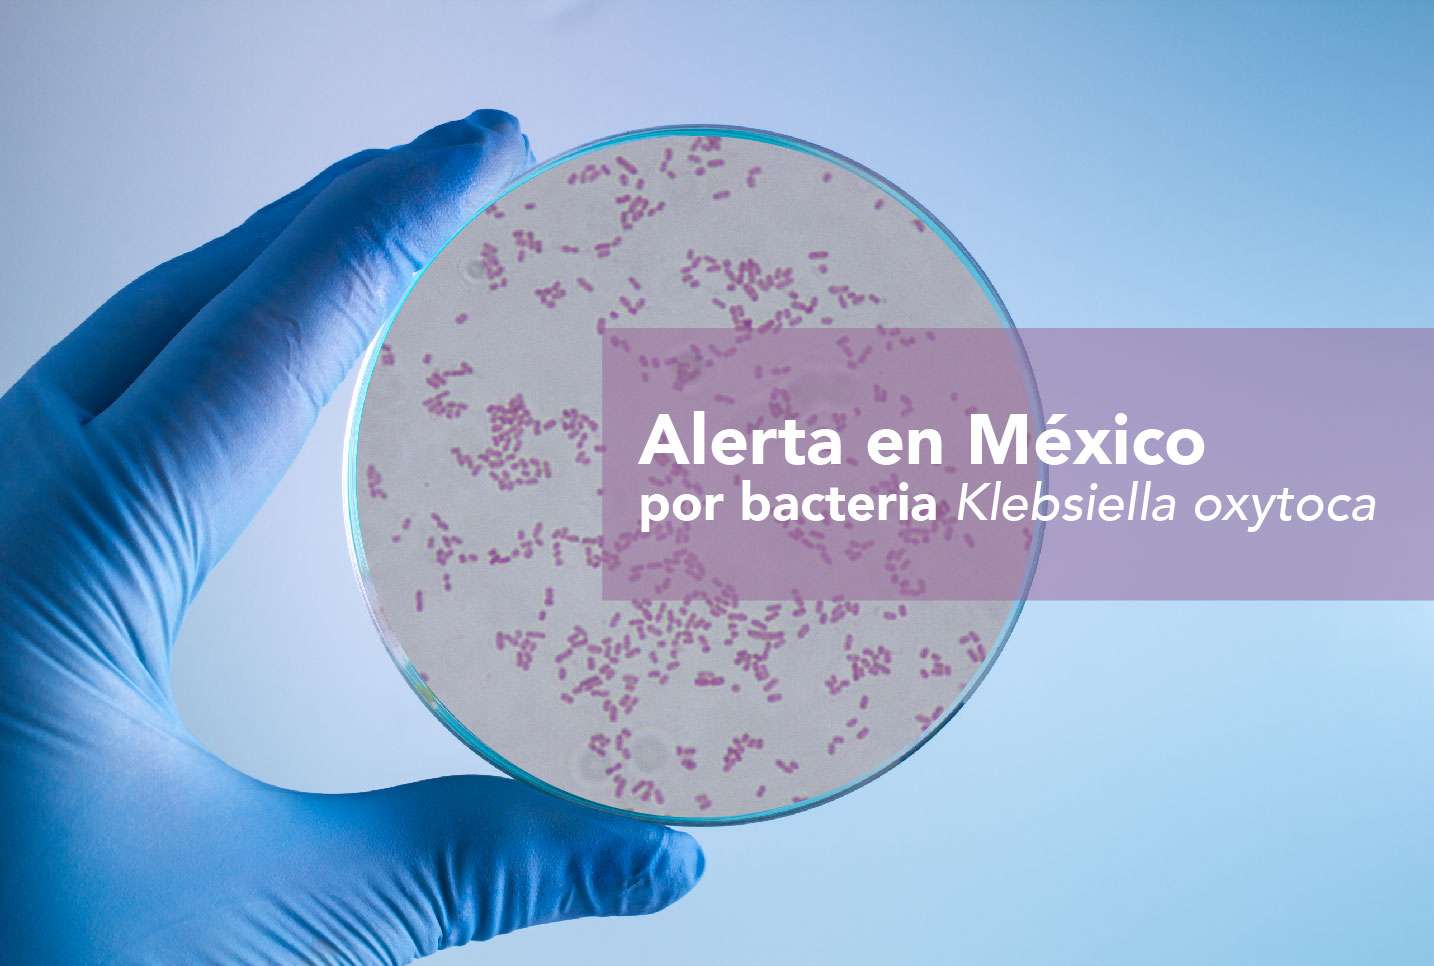

“Existen muchas bacterias que se encuentran en el organismo y en los animales, causantes de diferentes infecciones o como comensales; el intestino humano es hospedero de una gran cantidad de microorganismos que lo habitan de forma natural, entre ellos la Klebsiella oxytoca, un bacilo gram negativo responsable de infecciones en pacientes hospitalizados o inmunocomprometidos”, aseguró la doctora Rosa María Wong Chew, Jefa de la Subdivisión de Investigación Clínica de la División de Investigación de la Facultad de Medicina de la UNAM.
El pasado miércoles, la Coordinación de Comunicación Social, organizó una sesión informativa, debido a la alerta epidemiológica que la Secretaría de Salud emitió a través del Sistema Nacional de Vigilancia Epidemiológica (SINAVE) el 3 de diciembre del 2024, en el cual informó sobre el “Brote de Infección del Torrente Sanguíneo por Klebsiella oxytoca relacionado a posible contaminación de Nutrición Parenteral (NPT) o insumos relacionados con su aplicación”.
Durante el evento transmitido por YouTube y Facebook Live, la doctora Wong Chew mencionó que las manifestaciones asociadas a este microorganismo van desde infecciones de vías urinarias, neumonía, especialmente en personas que tienen alteraciones previas o neumopatías como EPOC o displasia broncopulmonar en los niños, infecciones de piel y tejidos blandos, como celulitis, hasta sepsis, es decir, la presencia de la bacteria en el torrente sanguíneo que da una infección generalizada.
De acuerdo con información de la doctora Wong Chew, el 28 de noviembre se reportaron a la Dirección General de Epidemiología (DGE), casos en 3 hospitales materno infantiles del Estado de México, para el 29 de noviembre ya había 19 casos en 4 unidades (3 públicas y 1 privada), de los cuales 15 ya han sido confirmados, 4 probables y uno descartado: “La mayoría de estos se han presentado en niños de 0 a 14 años, principalmente en neonatos con nutrición parenteral y datos de sepsis. Además, se ha descrito la identificación de la bacteria en las preparaciones adquiridas de las farmacéuticas.
La doctora Wong Chew ofreció algunas recomendaciones encaminadas a la prevención de Infecciones Asociadas a la Atención a la Salud (IAAS), basadas en recomendaciones de la OMS, para evitar o disminuir las bacteriemias relacionadas con catéteres vasculares, con la higiene de manos antes y después de cualquier procedimiento relacionado con dispositivos intravasculares, reducir el uso innecesario de catéteres, vigilancia y monitoreo, educación del personal, tratamiento y manejo, y comunicación de riesgos y trabajo en equipo.
“Es un brote muy localizado en el Estado de México, el problema con estas bacterias productoras de BLEE´s o multirresistentes es que generan enzimas que inactivan a diferentes grupos de antibióticos como las penicilinas o cefalosporinas y para este caso también los aminoglucósidos, lo que confiere un problema importante y un reto para el personal de salud, porque los antibióticos comúnmente usados en el tratamiento no tienen una respuesta adecuada, situación que puede generar complicaciones como la sepsis, choque séptico e incluso la muerte”, indicó la doctora Wong Chew.
Las infecciones por Klebsiella son un problema de salud pública importante, principalmente en el ámbito hospitalario, debido a su frecuencia, gravedad y resistencia a los antibióticos, lo que hace que el tratamiento sea más difícil. Por ello, es fundamental implementar medidas eficaces de prevención y control para reducir el riesgo de infección y garantizar que los tratamientos sean efectivos.La DGE solicita una notificación inmediata por las unidades de atención médica públicas y privadas que tengan un caso de sepsis debido a K. oxytoca productora de betalactamasa de espectro extendido (BLEE) o multirresistentes, a la Red Hospitalaria de Vigilancia Epidemiológica (RHOVE), a través del correo [email protected] y/o a la Unidad de Inteligencia Epidemiológica y Sanitaria (UIES) al correo [email protected].
(Información de Gaceta Facultad de Medicina, UNAM)

![[Negocio redondo]](/__export/sites/laopcion/img/2026/03/05/PCBwHEtG7yfAUgub.jpg?v=3)
[Negocio redondo]
Resulta que las detenciones de conductores ebrios han disminuido considerablemente porque los oficiales de la Policía Vial, quieren evitar la fatiga, como decía Jaimito El Cartero, el personaje de la serie de El Chavo del 8.
Dicen que los policías ya no quieren llevar a los conductores ebrios a la delegación para evitar la pérdida de tiempo, que, en ocasiones, se lleva hasta medio turno y pues así la casa pierde $.
Cuando ya de plano no hay de otra más que llevar al conductor borracho a la delegación, después de intentos e intentos de llegar a un arreglo $ en la calle, pues ni modo, lo llevan.
Comentan que hay broncas con los accesos en las claves para ingresar en las computadoras de vialidad, aunado a que algunos polis no se les da el uso de esos aparatejos, así que tienen que pagar algunos cientos de pesos al oficial de guardia para que les haga la chamba, que es elaborar el llamado IPH (Informe Policial Homologado) que awiwi tiene que subirse a la página de la Secretaría de Seguridad y Protección Ciudadana y quede en el Registro Nacional de Detenciones, de no ser así les cae bronca, hasta de secuestro los pueden acusar.
Foto ilustrativa


EL REGRESO DE RUSH
Anika Nilles, la sucesora de Neil Peart
Por: Chamuco
Vaya polvareda que levantó el inesperado –pero muy grato- anuncio por parte de Geddy Leey y Alex Lifson (bajista/vocal y guitarrista de Rush, respectivamente) con relación a que la banda canadiense había encontrado baterista para acompañarlos en una gira para conmemorar los 50 años de la banda y así mismo, celebrar el legado de Neil Peart.
Ah, y anunciaron también que cuentan con las bendición de la viuda y la hija de Neil, Carrie Nuttual- Peart y Olivia Peart.
La roqueriza de medio cachete se quedó pasmada ante tal revelación. Resucitó una de las bandas más grandes y más queridas de la historia, precisamente cuando todos pensábamos que habían llegado a su fin. No conozco un rockero que no lo haya celebrado, incluyéndome.
Pero, ¿cómo se llegó a ese punto? ¿Cómo se gestó el regreso de Rush? ¿Quién será el osado que intente ocupar el lugar del “Profesor”? ¿Acaso piensa que puede salir bien librado ese temerario? Se preguntaban los rockercillos, incrédulos todavía de lo que se anunciaba.
Todo inició cuando con motivo de la muerte del baterista Taylor Hadwkins en Colombia –estaba muy chilosa la salsa-, organizaron un concierto para homenajearlo el 3 de septiembre de 2022.
Participaron, entre otros, los miembros de Rush, y nada más y nada menos, que el mejor músico y compositor que haya pisado la faz de la tierra, Sir Paul McCartney. –Le guste a quién le guste-.
Los canadienses no conocían a Sir Paul, y al darse la coyuntura, no perdieron oportunidad de hacerlo. Según comenta Geddy, Sir Paul y Alex estuvieron charlando durante bastante tiempo, y mientras bebían -con recato y con mesura-, Paul los instaba a superar el duelo y volver a los escenarios. Ya ven lo que siempre dice Ringo, esto es lo que hacemos –exclamó Macca.
Por aquellos días, el técnico de bajo de Geddy, John “Skully” McIntosh había trabajado en la última gira del fantástico guitarrista Jeff Beck, le comentó a Geddy que había trabajado con una baterista extraordinaria en la gira de Jeff Beck, y que, aunque sabía que no estaba en planes regresar a los escenarios, no sería mala idea echarle un vistazo.
Al hacerlo, se sorprendió por su técnica y su groove, por lo que cuando se reunió con Alex, le mostró los videos de la baterista, una desconocida sin mayores cartas credenciales que haber tocado con Jeff Beck (casi nada), llamada Anika Nilles.
Aunque no estaba en sus planes, quizá Yoda –o Sir Paul para los mortales- tenía razón. Era momento de regresar a pisar los escenarios.
Sin tanto rollo contactaron a Anika y le preguntaron que si quería ir a Canadá para hacer uso ensayos “sin compromiso”. No puedo imaginar el gesto facial de Anika al saberse invitada a ensayar con una de las bandas más legendarias de todos los tiempos en el lugar de quién fuera clasificado como el mejor baterista del mundo por décadas.
Volviendo un poco el tiempo atrás, Alex y Geedy declararon que, al poco tiempo de la muerte de Neil, recibieron varios correos electrónicos de “bateristas renombrados” los cuales se ofrecieron para ocupar el lugar de Neil Peart. Cuales buitres carroñeros, aún no se enfriaba el cuerpo del Profesor cuando ya andaban sobrevolando en círculos sobre su cadáver. Cabrones.
Por ahí, de la nada, y a lo pendejo, un Mike Portnoy declaró en algunas entrevistas que él nunca había buscado sustituir a Neil Peart en la banda. A explicación no pedida, confesión manifiesta mi Maic!
Una vez que Anika llegó a Canadá para los ensayos, se tomaron un par de días para “romper el hielo”. Después ensayarían durante 5 días más, para ver si se daba la química musical necesaria y ver si encajaba bien su estilo con el alma de Rush.
No buscaban imitadores, estaban muy conscientes que había cientos de ellos que podrían imitar al Profesor, sin embargo, ellos buscaban alguien que si bien respetara la estructura ósea de las canciones, también le diera su toque personal a las mismas.
Aunque desde un primer momento hubo buena relación con Anika, durante los primeros días de ensayo las cosas no salieron como lo pensaban. Anika estaba muy nerviosa y ellos un poco inseguros.
De alguna forma u otra, la formación, y principalmente la relación que existe entre el bombo, la tarola y los hi-hats eran muy distinta a la que tenía Neil y eso de cierta forma los afectaba, ya que tenían décadas y décadas bajo el metrónomo del Profesor.
Cuando terminaron el ensayo del 4to día, se reunieron Geddy y Alex y el primero le comentó al segundo que quizá no había sido una buena idea lo que estaban haciendo. No estaban seguros y aun no se sentía esa magia que solo aquellos que tocan en una banda saben a lo que me refiero.
Pero al quinto día todo cambió. Anika estaba más segura de sí misma, y Alex y Geddy, un poco más relajados. Cuando a medio ensayo le dijeron que seguía Tom Sawyer, -al estar consciente del peso significativo de esa canción en la banda- cascabeleó, le temblaron sus rodillas y apenas puedo decir: “no sé si quiera tocar esa”, y cuando se dio cuenta que ahí no era restaurante “para pedir los huevos al gusto” no tuvo de otra más que marcar con las baquetas y voilá!
En ese momento dio en el clavo. Según Geddy y Alex, comprendió lo que le venían pidiendo desde el día 1. Sin darle tantas vueltas, ahí se tomó la decisión de que fuera reclutada como la nueva baterista de Rush, y no solo un reemplazo de Neil.
Se quedaron sobrevolando los buitres. Unos apostaban a que llegaría Mike Portnoy, otros, a la llegada de Mike Mangini, unos más aseguraban que sería Dani Carey, pero no, llegó una mujer completamente desconocida, con una personalidad más bien gris –igual a la de Neil Peart-, pero con unas agallas, con las cuales no tengo la menor duda de que cumplirá –con algo más que la decencia-con el manejo de las baquetas sobre lo tambores.
Nomás de curioso quise conocer la opinión de dos de mis amigos quienes, ambos Rushomános consagrados, de cepa. Vladimir Terrones y Saúl Rodríguez fueron los elegidos para preguntarles cual es su expectativa respecto a la nueva integrante. Ambos llegaron a la conclusión de que si bien es cierto de que es una música extraordinaria, difícilmente podrá llenar el gran vació que dejó Neil Peart, aunque la idea no sea suplantar a nadie.
Mi opinión es un poco distinta. Recordemos que Neil no es el primer baterista de la banda. John Rutsey fue su primer baterista y tuvo que abandonar el barco debido a sus problemas de salud. Con feeling, Alex y Geddy pudieron encontrar en Neil Peart a su nuevo baterista y no erraron.
En esta nueva etapa considero que tampoco lo harán, pero…
Aquí la pregunta que casi nadie se hace… ¿Y las letras, apá?
Recordemos que casi el 100% de las letras de la banda fueron escritas por Neil, aportando en su totalidad la identidad lírica de la banda. Ahí está el quid del asunto.
Mientras tanto se nos viene encima una gira mundial de gran calado y estoy seguro que un nuevo disco de Rush ya se está horneando. Al tiempo.
Bienvenida Anika Nilles! Larga vida para Rush!
Comentarios: [email protected]

ANGINE DE POITRINE Live on KEXP. Reseña. (2025)
Por Chamuco
La KEXP es una estación de radio independiente sin fines de lucro ubicada en Seattle, Washington. Su misión principal es la difusión de bandas emergentes poco convencionales, lo que la hace un oasis para todos aquellos melómanos ávidos de propuestas más allá de lo común, masivo y comercial.
Al buscar una presentación en vivo de una de mis agrupaciones predilectas –King Gizzard & The Lizard Wizard- tuve la suerte de descubrir esta gran banda llamada Angina de Pecho –un dolor en la caja torácica causado por la falta de flujo sanguíneo a la corazón.
De reciente data, este dúo anónimo canadiense rompe con toda convencionalidad musical.
Compuesto por dos hermanos –quienes utilizan los seudónimos de Khn de Poitrine (guitarra y bajo micro tonales y Loops) y Klek de Poitrine (batería)-, su propuesta la definen como Orquesta Micro Tonal-Dada-Pitago-Cubista, lo cierto es que es difícil de encasillar, aunque les doy la razón de ser Dadaístas y podría afirmar que oscilan entre el Math Rock, el Rock Progresivo, el Rock Experimental, el Rock Psicodélico y Avant-Garde con disonancias armónicas, ajajaja. . ¡¡¡Vaya ortodoxia!!!, ladró mi Charlie.
Su primer álbum (VOL. 1) fue publicado apenas en 2024, y en este 2026, nos agasajan con su nueva producción (VOL. 2), manejando la misma línea y calidad que su antecesor. Ambos son extraordinarios. Exquisitos.
Sin embargo, hoy nos referimos a su presentación del pasado 4 de diciembre de 2025 en el ESMA en Rennes, Francia, y transmitida por la ya mencionada KEXP.
La presentación consta del siguiente repertorio:
1.- Sarniezz 00:32
2.-Mata Zyklek 06:10
3.- Fabienk 13:09
4.- Sherpa 20:33
Ataviados en estrambóticas túnicas aderezadas por miles de puntos y máscaras de papel maché, este grupo –en pleno desarrollo- pareciera estar destinado a lograr un espacio en el firmamento de la música no-comercial. Notoriamente influenciados por los Lizzard Wizzard , algo de The Residents y en cierta medida por una etapa en particular de un gigante llamado Frank Zappa, esta banda –innovadora, rara, hermosa- merece la oportunidad de escucharla con audífonos y sin tener a la mano ese aparato tan nocivo e idiotizante llamado teléfono móvil. Al inició señalé el uso de bajo y guitarra micro tonales. Y eso que es? Se come, se bebe o se fuma? – preguntó Frijol-.
Pues bien, desconocida por la gran mayoría de músicos – y el que lo niegue, miente-, la música micro tonal requiere no solo de los conocimientos sino también de instrumentos musicales fabricados ex profeso para su ejecución.
Orgullosamente un mexicano, compositor e inventor de instrumentos musicales oriundo de San Luis Potosí llamado Julian Carrillo –no solo es el nombre de una calle del centro de nuestra amada ciudad-, desarrolló un sistema que divide la octava en fracciones mucho menores a semitono (cuartos, octavos y dieciseisavos de tono), alcanzando su opus magna en el año de 1895 con su “Sonido 13”, para lo cual fue necesario la construcción de instrumentos no convencionales para poder ejecutarla.
Como referencia a Don Julián, me permito adjuntar abajo un enlace como referencia –y que si prestan atención, podrán percibir la ilusión auditiva que puede obtenerse mediante el uso de las micro tonalidades, las cuales nos permiten explorar afinaciones que engañan al cerebro al presentar alturas, armonías y progresiones qué no existen en la música tradicional occidental de 12 tonos, de tal forma que no solamente se escucha, sino que se “siente” de maneras inusuales, manipulando la forma en la que el cerebro procesa el tono y el timbre. De formas más simple es como si en toda la historia de la música occidental siempre una pizza fue cortada en 12 rebanadas y Juliancito, cabroncito como él solo, la partió en 13 y amplió el espectro de posibilidades a los compositores, con la desventaja que se requieren instrumentos únicos para ello. Espero haberme dado a entender. Agur.
Acá el enlace de la presentación de Angine de Poitrine.
https://www.youtube.com/watch?v=0Ssi-9wS1so&t=88s
Aquí en enlace de Julián Carillo.
https://www.youtube.com/watch?v=1TC4OGMLt2o
Akiki otro enlace de mi composición favorita de Carrillo.
https://www.youtube.com/watch?v=yZrRApFNPLs&t=156s
Post data: Tienen una forma muy peculiar de saludarse entre ellos y al respetable. Forman un triángulo con sus dedos a la altura de su frente y emiten sonidos guturales muy chistosos. JAJJAJAJAJA, Geniales y muy piratones!
Comentarios: [email protected]

In The Beginning. (2020. Hardcore/Metal) Reseña
Por El Chamuco
Cro-Mags es agresividad pura, sin concesiones. Sus letras –crudas todas ellas- abarcan temas de superación personal. Resiliencia, resistencia, integridad, autodeterminación, autenticidad ante la falsedad, amor propio, permanencia a nuestras convicciones, y principalmente, la no rendición ante cualquier adversidad. Y de ahí no salen.
Sin embargo, antes de hablar de la banda o del álbum, es preciso hacerlo antes de Harley Flanagan, su fundador, bajista, vocalista y compositor. Personajazo.
Hijo de un alcohólico ladrón de poca monta y de una actriz y escritora perteneciente a la bohemia neoyorkina de los años sesentas y setentas, no era raro ver al pequeño Harley en tertulias junto a Andy Warhol (se adjunta fotografía), y algunos otros artistas y poetas de la generación Beat. –
A la edad de 7 años, el buen Harley escribió su primer libro de cuentos “Stories and Illustrations by Harley”, siendo prologado por el aclamado poeta Beatnik, Allen Ginsberg –casi nada-.
A los 9 años de edad, este mozalbete ya se había convertido casi en la mascota del legendario CBGB. No era raro verlo en el club a sus 9 o 10 años de edad, conversando con figuras rutilantes del recién nacido punk, tales Debbie Harris (Blondie), el mismísimo Andy Warhol –a quién ya mencionamos-, o Joe Strummer de los Clash, solo por mencionar algunos. (Se adjuntan fotografías). Esa etapa de su niñez la vivió entre Nueva York y algunos lugares de Europa, siempre acompañado por su madre. Siempre entre artistas, locos y bohemios.
A la edad de 11 años, fue invitado, o mejor dicho, se le avisó de que a partir de ese momento se convertiría en el baterista de una banda sui generis de punk llamada Stimulators, la cual estaba conformada por dos mujeres, un homosexual y un niño, ja! Fue reclutado por su tía Denise Mercedes, quién era una de las guitarristas.
Grabaron un EP de 7” titulado Loud, Fast, Rules. Aquí se deja el enlace para quién le interese.
https://youtube.com/playlist?list=PLDfgdXn7XEXx3yQgu-CeAilEfYTFh1gNT&si=M_eNKAXjev7T4Di7
Al poco tiempo, el niño Harley tuvo a bien formar Cro-mags, cuya alineación clásica podría ser John Joseph en la voz (Hare-Krishna también), Mackie Jayson en la guitarra, Parris Mayhew en la otra, y nuestro protagonista al bajo.
Sus primeros dos discos The Age of Quarrel (1986) y Best Wishes (1989) son considerados de culto dentro de la escena Hardcore –aunque el Best Wishes es más metal que Hardcore-.
Tanto Harley como John, son practicantes de la filosofía-religión Hare-Krishna y del movimiento Straigtht Edge (una subcultura dentro del Hardcore que prohíbe el consumo del alcohol, tabaco o cualquier otra sustancia que altere la conciencia, promueve el veganismo, así como la prohibición de la promiscuidad sexual), lo cual se ve reflejado claramente en la temática de sus discos.
Al andar por los andares de la vida, tuvieron serias diferencias y empezaron los problemas legales relacionados con el uso del nombre de la banda. La situación que se fue agravando, hasta que el el 12 de septiembre de 2023, en el CBGB FESTIVAL lo arreglaron como gente civilizada y sensata..
¡¡¡a cuchillo y mordida limpia!!! Jajajajaja. Parece chiste pero es verdad. Aquí un enlace que da cuenta de lo sucedido:
https://consequence.net/2023/09/cro-mags-harley-flanagan-violent-altercation-staff-music-magazine/
Luego de varias investigaciones e inconsistencias en las declaraciones de los testigos, terminaron por retirar los cargos, sin que haya quedado del todo claro los hechos y la responsabilidad de Flanagan en los mismos.
Actualmente es instructor de Ju-Jitsu en la Academia Renzo Gracie de Manhattan.
En el año 2024 se estrenó el documental Harley Flanagan: Wired For Chaos, en el que se narra la vida de Harley desde la perspectiva del director Rex Miller, así como la de otros artistas como Flea (Red Hoit Chilli Peppers), y Henry Rollings (Black Flag), entre otros. Aquí el enlace del Tráiler:
https://youtu.be/ojOfP12Glok?si=Li1zbM4qJHSw2u9
In The Beginning…
El 19 de junio de 2020, a través del sello Mission Two Enterteiment, fue publicado In The Beginning. Contó con la producción de Arthur Rizk y del propio Flanagan.
Pues bien, ya con Harley Flanagan al mando de la banda, tuvo a bien reconformarla de la siguiente manera:
Bajo/vocales y composición: Harley Flanagan.
Guitarra: Gabby Abularach
Bateria: Garry “G-Man” Sullivan
Guitarra Líder: Rocky George. Ex guitarrista de Suicidal Tendencies.
La portada del disco es una fotografía de un edificio quemado en Nueva York en el que Flanagan vivió cuando tuvo a bien escapar de su “hogar”, a muy temprana edad.
La obra es un puñetazo en el rostro de principio a fin. Tal cual. Empecemos.
1.- Don’t Give In. Por más jodidas que vayan las cosas, sigue adelante, sigue luchando, pero no te rindas jamás, -vocifera un Flanaggan lleno de ira- mientras la banda nos muestra su evolución con una tendencia mas hacia el metal.
2.- Drag Your Under. Rápida y potente -con ciertas reminiscencias de Suicidal Tendencies-, trata sobre la necesidad de terminar con la autocompasión, levantarse y darle de frente y sin miedo a la vida. Ponchada, muy buena.
3.- No One’s Victim.- Solo la muerte es segura, lo demás es opcional. Tu felicidad depende de ti y de nadie más, así que no se “vistimice” y haga caso al buen Harley. Uno de los mejores cortes del álbum. Acá el video oficial: https://youtu.be/86awYZJm1Tw?si=QLCVpWUlXU5lbqVi
4.- From the Grave (Ft. Phil Campbell). Hardcore/Metal de alta manufactura. El señor Campbell (guitarrista de Motorhead) colabora con un solo de guitarra exquisito. Las derrotas no siempre son definitivas ni la victoria es permanente. En tiempos de paz, prepárate para la guerra. Ay nanita!
Es la pieza que mas me gusta del disco. Ufa Maruja, que cosas!!! Enlace al video:
https://youtu.be/5zMEshmiobg?si=WdVXXqLiICnyB4Ou
5.- No One’s Coming. Lo que no hagas por ti mismo, nadie lo hará – el berrea el buen Flanagan-. Sigue la misma línea, es potente, agresiva, con coros bien logrados y un solo del señor Rocky George destacable. La última cuarta parte de la pieza es buenísima pero difícil de describir. En mi opinión deambula entre los terrenos del progresivo y el experimental, siempre dentro de la esfera del Metal. Este nuevo Cro-Mags no solo hace hardcore, sino cosas ya más complejas y mucho más elaboradas de lo que cualquiera pensaría –dada la naturaleza de la banda-.
6.- PTSD. La canción -al menos en mi opinión- aborda la problemática de aquellas personas que al regresar de combatir en una guerra, sufren los estragos mentales al haber vivido experiencias traumáticas. Trata del dolor, la rabia, el arrepentimiento y la culpa. Intensa.
7.- The Final Test. Tiene una fuerte carga Krishna y musicalmente recuerda a Bad Brains. En esta pieza, Flanagan, reflexiona acerca de la paz mental y el amor con el que se debe enfrentar el ser humano, al momento de du muerte. Excelente.
8.- One Bad Decision. Rápida y con muy buenos coros. Sé cuidadoso de lo que dices, sé cuidadoso de lo que haces. Los sueños se van en un segundo. La canción trata acerca de las consecuencias que pueden tener nuestras malas decisiones. Buena pieza.
9.- Two Hours. Plantea el “¿Dónde quieres estar dentro de 2 horas? ¿Sentado en una celda?” Plantea la idea del cambio radical que puede darse en nuestra vida o en la de alguien más por alguna decisión estúpida en nuestras vidas. Ligada intrínsecamente a la anterior, musicalmente es una joya que pudiera ser sacada de alguno de los mejores álbumes de Suicidal Tendencies. Me hubiera gustado ver la expresión de Mike Muir al escucharla. JAJAJAJAJA. Buenisima.
10.- Don´t Talk About It. En su momento se te ofreció la paz. ¿No quisiste? No busques ahora compasión. Vuelve a destacar la colaboración de Rocky George. Tiene un final con ciertos aires árabes. Muy buena.
11.- Between Wars. 5:50 minutos de arte. Algo que jamás esperarías escuchar de una banda de Hardcore. Todos muestran sus habilidades, pero Garry Sullivan, (batería) nos ofrece unas percusiones espectaculares. Excelente. Pachequisima.
Aquí el enlace: https://youtu.be/QG6LQmkRY7k?si=AnO3M_C20LxKcE2y
12.- No Turning Back. Lenta. Recuerda en momentos –al menos para mí- a Alice in Chains. Muy buena.
13.- There Was a Time. Vaya forma de cerrar el álbum. Los ladridos de un perro dan inicio a una artillería de metal, mediante la cual, Flanagan nos recuerda que la vida puede cambiar de un segundo a otro, y puedes perder tu vida y a quienes amas. Buen cierre. Gran álbum. Muy recomendable.
Harley ha manifestado en varias entrevistas que el escribe para sí mismo, en un ejercicio de
Celebro que existan propuestas artísticas que impacten de forma positiva a la sociedad y que el entretenimiento no solamente sea eso, sino también un aliciente para personas vulnerables por los problemas, la ansiedad o la depresión. No solo son gritos.
Puntuación: 9/10
Comentarios: [email protected]

IRON MAIDEN. LIVE AFTER DEATH. 1985. 40 ANIVERSARIO. RESEÑA
Por: Chamuco
Después de haberse forjado un nombre en el circuito de la emergente New Wave Of British Heavy Metal con sus primeros álbumes Iron Maiden (1980), Killer´s (1981), The Number of The Beast (1982), y Piece of Mind (1983), la banda sabía que tenía las credenciales necesarias para terminar de consolidarse a nivel mundial, y decididos a ello, en 1984 publicaron Powerslave -un álbum inspirado en la temática egipcia- y se embarcaron en la gira World Slavery Tour 1984-1985, la más extensa en toda la historia de la banda- 187 conciertos en 24 países en poco menos de un año-.
Aunque ya habían publicado con anterioridad un álbum en vivo, Maiden Japan (1981) –un juego de palabras como homenaje al disco de Deep Purple, Made in Japan (1972), producido por el mismo Martin Birch-, su repertorio se limitaba únicamente a canciones contenidas en los únicos dos álbumes publicados hasta ese momento, y al hecho de que fue grabado cuando aún Paul Dianno se encargaba de la voz.
Iron Maiden había evolucionado en muchos sentidos y esta era la oportunidad que tenía la banda para demostrarlo al mundo y terminar de consolidarse. Después de algunos cambios, se conformó la alineación clásica de la banda: Steve Harris (bajista y líder absoluto del grupo), Nicko McBrain (batería), Adrian Smith (guitarra), Dave Murray (la otra guitarra, jeje) y Bruce Dickinson (voz); y ese, era su mejor momento.
No obstante al éxito que ya habían alcanzado, decidieron llevar a la banda a otro nivel y decidieron registrar en audio y video su espectáculo para mostrarlo al mundo entero.
Ron Smallwood -su manager de toda la vida- tenía bien marcado el plan de ruta y logró que la gira lograra penetrar la cortina de hierro –algo insólito- presentando a Iron Maiden en Polonia, Yugoslavia y Hungría. Añeñe.
Con la precisión de una pieza de relojería, para la gira planificaron una producción faraónica -literalmente-, que incluía varias escenografías egipcias, pirotecnia y 2 Eddys gigantes, uno, de 3 o 4 metros de altura que deambulaba entre los integrantes de la banda en el escenario y uno más, de mayores proporciones, situado atrás de la batería de Nicko McBrain, y que aventaba chispas de sus ojos. Una locura para la época.
La grabación de Live After Death se realizó mediante la contratación del Rolling Stones Mobile Studio y se grabaron tomas en el mítico Hammersmith Odeon de Londres, y en el Long Beach Arena de California.
La producción corrió a cargo de Martin Birch, quién ya les había producido casi todos sus álbumes y también ya había producido a bandas de la talla de, Black Sabbath, Rainbow, Whitesnake, y de Deep Purple, como ya se mencionó, entre muchas otras.
La portada del disco –extraordinaria y atemporal-, corrió a cargo del gran artista plástico Derek Riggs, responsable de realizar las mejores portadas de la banda en toda su existencia.
La portada del álbum, es una representación de Eddy The Hunter saliendo de una lápida y siendo alcanzado por un rayo en la frente, rodeado de fuegos fatuos.
En la lápida podemos observar inscrita la cita “No está muerto lo que yace eternamente, pero con el pasar de los extraños eones, aún la muerte puede morir”, la cual pertenece al cuento “La llamada de Cthulhu” del maestro de la literatura de terror cósmico H.P. Lovecraft.
Dicha portada, según el propio Riggs, está parcialmente inspirada en la obra La Destrucción de Sodoma y Gomorra del pintor John Martin, lo cual es perceptible solamente si se observa la portada y contraportada juntas.
Este añose celebran los 40 años de la publicación de esta obra de arte y aunque tardía, esta columna lo celebra. Vamos pues.
...ARRANCATE MARIACHI!
1.- Churchill´s Speech (Intro). El concierto inicia con el sonido de aviones sobrevolando durante algunos segundos, posteriormente, da inicio el histórico discurso que el 4 de junio de 1940, el gran Winston Churchill pronunció ante la Cámara de los Comunes del Parlamento Británico. En el discurso, -conocido como Lucharemos en las Playas-, Churchill se dirige a su pueblo para anunciarle la intención de la Alemania Nazi por invadirlos, así la férrea defensa que harán para impedirlo, así como su promesa de jamás claudicar ante los invasores.
Al concluir las palabras de Churchill -ligada al discurso-, inmediatamente da inicio: 2.- Aces High, una canción inspirada en La Batalla de Inglaterra, - el combate aéreo más grande de la historia-, donde la Luftwaffe intentó, sin éxito, destruir a la Real Fuerza Aérea Británica, hechos relacionados directamente con el discurso, ya que dicha batalla fue precisamente la fallida intentona alemana de invadir.
Desde los primeros acordes, la música hace que la piel se le ponga a uno chinita. Lo digo de verdad. Es un inicio emocionante que va marcando el nivel de lo que vendrá.
Al margen, cabe mencionar que la calidad de la grabación es impecable, nítida y cristalina. Cada uno de los instrumentos se percibe con una nitidez y una claridad pocas veces escuchada en cualquier grabación de aquellos ayeres. En los audífonos -como se debe escuchar un álbum debidamente- es un deleite poder escuchar en el canal izquierdo la guitarra de Dave Murray y en el derecho la correspondiente a Adrian Smith. Es fácilmente perceptible y gratificante poder escuchar como intercalan el papel de guitarra líder y el de guitarra rítmica entre ellos. Así como lo hacen los Stones.
No obstante, al margen de lo bien lograda que salió la grabación, Steve Harris fue muy enfático con Martin Birch en el sentido de que se opuso férreamente al hecho de que la gran mayoría de los errores de grabación fueran editados en la postproducción para corregirlos, toda vez que la intención final de la banda, -y de Harris, principalmente-, era poder ofrecer una grabación en vivo que fuera lo más cruda y genuina, que pudiera capturar así, -lo más parecido posible-, la experiencia de escuchar a la banda como cualquiera de los asistentes ahí presentes lo hicieron.
Lo anterior, es más perceptible en el caso de Bruce Dickinson, cuya voz es “cruda” –sin efecto alguno-, y presenta varios errores a lo largo del concierto.
3.- 2 Minutes to Midnight. Siguiendo con la misma temática bélica, esta pieza hace referencia al Reloj del Apocalipsis, un instrumento simbólico real, que marca la cuenta regresiva hacía el fin de la humanidad. Su temática es una crítica hacia la escalada de la Guerra Fría, que por aquellos entonces estaba en su apogeo.
4.- The Trooper. Continuando con guerras, esta canción está basada en el poema de Lord Alfred Tennyson La Carga de la Caballería Ligera que a su vez, hace referencia a La Batalla de Balaclava, la cual se se llevó a cabo el 25 de octubre de 1854 dentro del marco de la Guerra de Crimea, dejando un saldo de 300 soldados ingleses caídos en combate. La letra, está escrita desde la perspectiva de uno de esos soldados.
5.- Revelations. Se trata del primer tema escrito por Bruce Dickinson dentro de la banda. Sus letras son introspectiva, místicas y esotéricas.
6.- The Flight of Icarus. Inspirada en el mito griego de Ícaro y su padre Dédalo, quienes al estar presos en la isla de Creta, Dédalo le fabricó unas alas de cera a su hijo para que éste pudiera escapar de su cautiverio, sin embargo, Ícaro, víctima de su arrogancia, desobedeció las palabras de su padre y voló tan alto que sus alas fueron derretidas por el calor del sol, e Ícaro cayó al mar, muriendo por ahogamiento en el mar.
7.- Rime of the Ancient Mariner. Está basada en el poema homónimo de Samuel Taylor Coleridge de 1798. Cincelado magistralmente bajo la pluma de Steve Harris, narra la historia de una tripulación, que al navegar por el mar, se encuentran con un albatros volando sobre ellos y a partir de ahí, empieza la aventura… Cada quién sus gustos, pero a mí, me parece la mejor pieza de toda su discografía. Una obra de arte de principio a fin.
8.- Powerslave. Escrita por Bruce Dickinson y publicada en su álbum homónimo, trata de un Faraón moribundo que se cuestiona la razón por la cual, a pesar de ser un Dios, un ser de poder absoluto, no es capaz de poder evitar su propia muerte. Como dato anecdótico, la máscara de plumas que porta Bruce Dickinson al interpretar esta pieza, la compró ese mismo día al pasar caminando frente a un sex shop ahí mismo, en Long Beach, California.
9.- The Number of the Beast. Como casi todas las canciones de la banda, fue escrita por Steve Harris. Fue inspirada en una pesadilla que sufrió como consecuencia de ver, a altas horas de la madrugada, la película The Omen II, jajaja.
De igual forma, está inspirada también en el poema Tam o' Shanter del más grande poeta que haya aportado Escocia, Robert Burns.
La pieza inicia con una voz grave y profunda que cita los versículos Apocalipsis 12:12 y 13:18 para después, dar rienda suelta a una de las piezas de heavy metal más legendarias de todos los tiempos. Lumbre, diablos, no poder escapar... temazo! jajajaja
10.- Hallowed By Thy Name. La letra narra los pensamientos de un prisionero condenado a la horca, explorando sus sentimientos de miedo, la aceptación de su destino y reflexiones sobre la vida y la muerte. Para muchos seguidores de la banda, se trata de la Opus Magna de Iron Maiden.
11.- Run to the Hills. Otro himno inmortal de la Doncella de Hierro. Narra la brutalidad de la colonización Inglesa sobre las tierras de Norteamérica, tanto desde la perspectiva indígena, como de la colonizadora. Es una de las primeras canciones en las que Steve Harris nos regala ese ritmo galopante único en él, que emula perfectamente el sonido producido por las patas de los caballos al cabalgar. Vaya versión.
12.- Wrathchild. La rabia contenida en un adolecente por el abandono de su padre y un entorno roto son la esencia de este tema. No se extraña a Paul Dianno, con todo respeto.
13.- 22 Acacia Avenue. Basada parcialmente en el cuento homónimo de 1841 del maestro del terror Edgar Allan Poe. A un hombre, solitario y aburrido, -jarioso, pues- le recomiendan ir a buscar compañía con Charlotte, una prostituta que labora en un burdel ubicado en el número 22 de la Calle Acacia. Al conocerla, se enamora y busca la forma de sacarla de trabajar. La clásica. La secuela la componen Charlotte the Harlot, 22 Acacia Avenue, Hooks in You y From Here to Eternety.
14.- Children of the Damned. Inspirada en el libro de ciencia ficción “The Midwich Cuckoos” (1957) de John Wyndham, así como en la película homónima de 1963, es una balada potente que trata sobre niños con poderes sobrenaturales que son vistos como una amenaza por los demás y están condenados a su final. .
15.- Die With The Boots On. Trata sobre la valentía y resiliencia con la que se deben afrontar los problemas. No es lo mejor de la noche pero cumple a cabalidad.
16.- Phantom Of The Opera. Mucho tiempo antes de que Andrew Lloyd Weber llevara la obra a las marquesinas de Broadway, Harris y sus secuaces homenajearon la novela de Gaston Leroux mucho tiempo antes. Gran versión en vivo de este clásico.
17.- Sanctuary. Narra las peripecias de un fugitivo que busca refugio y protección de la ley, debido a un hecho traumático que le tocó presenciar. Aquí la banda cede ni un milímetro, y por el contrario, muestran una fuerza y una química musical extraordinaria. Bruce Dickinson sabe que cantar –y ahora grabar- tomazos de la era de Paul Dianno serán colados sobre el cedazo de los fanáticos y no pierde oportunidad de mostrar al máximo su capacidades vocales. Bravo. Grande el “chaparrito” de Bruce, no le quedaron para nada grandes los zapatos y su voz se ajusta a la perfección a las piezas en comento.
Iron Maiden es mi banda favorita y sin duda, este sería un disco que me llevaría a la tumba. Me recuerda a mi infancia, a mi adolescencia, sigue escuchándose actual, y a pesar de haberlo disfrutado miles y miles de horas a lo largo mi vida, no solo no me aburre, sino que me gusta más y así será para siempre.
Calificación: 10/10
Comentarios: [email protected]
Up the Irons!!!!

KISS - ACE FREHLEY- (1978) - RESEÑA
Por: Chamuco González.
El mundo no terminaba de recuperarse tras la muerte de Ozzy Osbourne, cuando al gran Jefe se le antojó escuchar rocanrcol y mandó llamar a Space Man. Fue una partida anticipada. Inesperada. Injusta. A pesar de haber vivido un estilo de vida salvaje y autodestructivo, se encontraba en buen estado de salud al momento de su muerte.
La piel de su rostro -curtida por el alcohol-, así como su panza de yegua taquera, daban fiel testimonio de una vida entregada a los excesos.
Sin embargo, hasta el final de sus dias, en sus entrevistas se le observó lúcido y coherente.
Su estado físico era aceptable, tomando en cuenta que al momento de su muerte contaba ya con 74 años.
Siempre alegre, divertido, era incapaz de hablar más de un minuto sin soltar un carcajada -contagiosa como pocas-, lo cual incomodaba de sobremanera a sus compañeros de banda, principalmente al megalómaniaco de Gene Simmons, quién siempre se obsesionó con transmitir una imagen de maldad.. según él, jaja.
Su humanidad encarnaba a un personaje venido del espacio. Algunas de sus guitarras lanzaban cohetes que estaballaban sobre las alturas, otrás más, expulsaban gigantes nubes de humo que cubrian el escenario, y algunas otras, emitían luz propia desde el cuerpo del instrumento. A titulo personal, es mi integrante favorito y quién sin lugar a dudas fue quién aporto el sonido Kiss a la banda. Al menos es mi humilde opinión.
Pues bien, para dar un poco de contexto, despúes de publicar el fantástico Love Gun en 1977, y estando en la cúspide de su carrera -lograron posicionar en una misma semana 4 de sus álbumes dentro de los Billboards y hacían millones de dolares vendiendodo todo tipo de mercancia relacionada con la agrupación-, Bill Aucoin, su manager, quiso exprimirle hasta la última gota al momento, y elevó miras. Su arrogancia no le permitió recordar la fábula de Ícaro. La vio pelada y le salió peluda, jejeje. Grave error, mister Bill.
Primero tuvo la “brillante” idea de publicar en un mismo dia -18 de septiembre de 1978-, un disco de solista compuesto y grabado por cada uno de los integrantes Kiss por separado.
Bajo ese escenario, Ace, quién solo había cantado en Shock Me, –una canción inspirada en el accidente que tuvo al sostenerse de un barandal electrificado en un concierto, y que casi le cuesta la vida- tenía frente a sí, la oportunidad de componer, tocar y cantar él solo en un álbum por primera vez en su vida y demostrar así -tanto a Paul como a Gene-, de qué estaba hecho el muñeco.
Puso manos a la obra y contrató en la producción al genial Eddie Kramer, quién ya había trabajado con Beatles, Rolling Stones, Jimi Hendrix, Zeppelin, y Kiss. Ahí nomás.
Reclutó a un extraordinario baterista de Sudafrica llamado Anton Fig -quién a la postre grabaría los discos Dynasty (1979) y Unmasked (1980)-, a un par de coristas, e ingresó (dotado de cantidades industriales de sustancias prohibidas y otras no tanto) a la mansión de Colgate, donde montó un estudio de grabación y puso manos a la obra.
Respecto al bajo, éste corrió también a cargo de Ace en casí todas las canciones, así como el sintetizador.
¿El resultado? una colección de 9 temazos –sin desperdicio alguno, dijeran los argentinos-, repletos de hard rock potente, ecléctico, y revelador, con fraseos de guitarra exquisitos, forjados en base a bends y vibratos como solo el hombre del espacio sabía hacerlo.
Aquí el enlace del álbum: www.youtube.com/playlist?list=PLDOKvyJ5DdJAeqxnml26S6a8VHRXwkDyf&si=AEbVkAVBlsjirsmP
Pasemos a ello, pues:
1.- Rip it Out. Me hubiera encantado ver la expresión facial de Gene y de Paul cuando escucharon los primeros 10 segundos de este disco. JAJAJAJAJAJAJA. Desde el inicio el álbum nos muestra alturas y nivel. Extraordinaria ejecución de cada uno de los instrumentos, Ace en su estado más puro. Rock and Roll!
2.- Speedin´ Back to My Baby. Si bien es cierto que desde a mediados del siglo anterior algunos compositores de musica concreta y electro acustica experimentaron con la reproducción en sentido contrario de algunas cintas, o “al reves”, para mayor comprension, fueron los Beatles quienes incursionaron por primera vez en la música popular con la pieza “I’m Only Sleeping”. Posteriormente Hendrix haría lo propio. Al ser grandes influencias de Ace, no es de extrañar este guiño a guisa de homenaje. Exquisita de principio a fin.
3.- Snowblind. Al igual que la homónima de Black Sabbath, hace referencia a la caspa del diablo, muy recurrida en aquellos tiempos por nuestro amigo Ace. Del groovie pachecón evoluciona y explota con grandes solos.
4.- Ozone. Aunque su primeros acordes tienen reminiciencias de Led Zeppelin, se transforma en algo distinto, más complejo y más raro. Su letra, a tono con la anterior, trata sobre el gusto de Ace por andar siempre en la luna.
5.- Whats On Your Mind? Una catarsis por desamor en la que Ace nos muestra cómo se hace el rocancol sin pretenciones. Se escucha la influencia de Sweet.
6.- New York Groove. Fue, por mucho, la que canción que mayor éxito alcanzó. No solo del álbum de Ace, sino también de los otros tres que se publicaron.
Originalmente grabada tres años antes por la banda de Glam Rock britanica Hello, fue incluída a insistencia de Kramer. El uso del Talk Box le aporta un extra que la hace aún más pegadiza. Joyita.
7.- I’m In Need Of Love. Desde los primeros segundos Ace introduce sonidos de guitarra aderezados con efecto delay que le dan un aire espacial a la pieza. Tranquila y potente de inicio, sirve de fondo para que Frehley nos regale una pieza donde destaca por la belleza de su canto. Evoluciona y acelera su tempo para que este extraterrestre ejecute uno de sus solos mas bellos jamás compuestos. Se lleva las palmas del respetable y sale del ruedo en hombros. Bravo!
8.- Wiped Out. Rara y extraordinaria al mismo tiempo. Única. Pareciera que fueron dos canciones distintas entre sí, que fusionó en una sola. Al inicio destacan unas risas del maestro que dan un toque único a la canción.
Tiene cambios de tiempo y contratiempos muy raros y su estructura musical es muy distinta a lo que se tocaba en aquellos ayeres. Muy loca pero muy, muy buena.
Deambula de un rock setentero con fuerte influencia glamera a un hard rock muy pesado, para regresar a lo glamero y así sucesivamente.
Una pieza poderosa, en la que el señor Frehley no tiene reparo alguno en demostrar porqué fue, y seguira siendo por los siglos de los siglos, un guitarrista fuera de este mundo, -como lo indica su apodo mismo-, y quién aportó, le guste a quién le guste, el sonido a la banda Kiss.
9.- Fractured Mirrow. Un paisaje instrumental que sirve como cierre de la obra. Sublime y transportadora, una belleza.
Contrario a los cálculos de Casa Blanca Records y de Eddie Kramer, las ventas no fueron lo que esperaron y resultó, de inicio al menos, un fracaso comercial en la historia de la banda. Como dato anecdótico, es necesario mencionar que parte de la estrategia de ventas por parte de Bill Aucoin, días despúes de la publicación de los discos de solistas, se anunció el estreno de la pelicula “Kiss Meet The Phantom of The Park” , una pésima producción cinematográfica digna de Bollywood.
La pelicula, debido a su paupérrima calidad -en todos los sentidos-, terminó por convertirse en una pieza de coleccionismo entre la Kiss Army. Aunque sobra decir que fue todo un fracaso comercial, a título personal me parece muy divertida, es tan mala que la convierte en una película cómica.
Con respecto a la públicación de los otros 3 trabajos, muy al margen, me permitiré dar mi opinión:
Paul Stanley publicó un muy buen disco de Hard Rock, muy al estilo de la banda por aquellos entonces. Discazo. 8.5/10
Gene Simmons, por su parte, grabó un disco desconcertando, por decir lo menos. Un poco Beatle, saliendose del molde compositivo que había venido manejando. Rock-pop. A mí no me gusta. Algunos de sus más recalcitrantes fánaticos, lo defienden a capa y espada, por lo que siempre consideré que lo anterior se debe a un gusto adquirido. 7/10
Peter Criss nos ofreció algo todavía mas arriesgado y alejado del sonido de la banda. Sonidos Pop, Soul, Rhythm and Blues y obviamemnte Rock and Roll fueron la apuesta de Catman, destacando su voz, que a mi opinión muy humilde, es la más bella de las 4. Le ponemos un 6/10.
No queda más que darle un 10/10 a esta obra maestra, que sin duda alguna, destaca como uno de los mejores dentro la historia de Kiss.
LARGA VIDA A PAUL DANIEL FREHLEY
ACE
Comentarios: [email protected]

THE REVENGE OF ALICE COOPER. (2025) RESEÑA
Por: Chamuco González
Contrario a la creencia popular, Alice Cooper fue una banda y no un proyecto solista, como lo conocemos hoy en día.
Su formación se remonta al año de 1964, cuando Vincent Furnier y Dennis Dunaway, dos mozuelos amantes del arte poco convencional -en especial del surrealismo-, sin la más mínima noción musical, deciden formar una banda de rock después de ver el fenómeno que causó la Beatlemanía en los Estados Unidos.
Vincent sería el vocalista y Denis el bajista. Reclutaron a Glen Buxton como guitarrista principal, y sumaron al proyecto a Michael Bruce como guitarra rítmica, y a Neal Smith en los tambores.
Publicaron Pretties for You (1969), Easy Action (1970), Love it to Death (1971), Killer (1971), School´s Out (1972), Billion Dolla Babies (1972) y su último álbum, Muscle of Love (1973), producciones que los catapultaron hasta lo más alto del firmamento, trayendo consigo plata, mucha plata, pero también estragos causados por los excesos y la difícil vida de sexo, drogas y rocanrol que toda estrella de rock, que se jacte de serlo, debe seguir de manera religiosa y con disciplina franciscana.
Hedonistas por convicción y nihilistas por consecuencia, con el paso del tiempo sus integrantes fueron perdiendo interés en el grupo, hasta llegar al punto de su desintegración, la cuas se llevó en buenos terminos.
Vincent Furnier, su vocalista, al verse solo, no tuvo más remedio que buscar músicos con quienes seguir adelante, y tuvo a bien, en el año de 1975, cambiar legalmente su nombre a Alice Cooper.
En esta nueva etapa como solista debuta con el magistral álbum conceptual Welcome to my Nigthmare, uno de los mejores discos de rock de toda la historia.
Pasarían 52 años y 23 álbumes en estudio como solista, para que volviera a reunirse la formación original –salvo Glen Buxton, que falleciera en 1997, pero que con el uso de la tecnología lograron insertar algunas de sus guitarras grabadas previamente en este álbum-, y publicar esta nueva entrega.
Fue el 25 de julio de este año cuando fue publicado The Revenge of Alice Cooper bajo la producción nuevamente de Bob Ezrin, quién fuera una pieza clave para llevar a la banda, de ser unos músicos estrambóticos con ideas delirantes, a estrellas de rock consolidadas.
De entrada, la portada del disco es inmejorable. Al más puro estilo de los carteles cinematográficos de películas de horror de los años cuarenta, el nombre del álbum es coronado por el de cada uno de los integrantes de la banda. Muy ad hoc con la temática que envuelve al personaje y a la banda en general.
El trabajo da inició con Black Mamba una de las mejores canciones que la banda –y que Cooper como solista-, haya grabado en toda su carrera. Con la colaboración del legendario guitarrista de The Doors, Robby Krieger, la pieza da inicio con unas lúgubres atmosferas emanadas del bajo de Denis y las guitarra de Buxton y de Krieger, que sirven como preludio para dar inicio a una obra maestra que bien pudo haber sido incluida en cualquiera de las producciones de la Alice Cooper Band, o inclusive, en el Welcome to My Nigthmare –su primer maqueta como solista-, sin que se notase algún cambio en el sonido o en la mística de la banda, a pesar de haber sido grabada, y aparentemente compuesta, 52 años después.
Sin lugar a dudas es una de las mejores canciones de toda la carrera de Alice Cooper, como banda y como solista.
Vaya producción de Bob Ezrin en Up All Nigth, una canción cuyo esqueleto compositivo podría ser hard rock clásico, pero que Ezrin adereza con unos riffs puramente alternativos de los años noventa con unos coros muy al estilo de los años sesentas, particularmente del subgénero Bubble Gum Rock. Un ejercicio de yuxtaposición musical donde se obtiene como resultado, una pieza fuera de lo común y muy bien lograda.
Kill The Flies por su parte, redonda, bien armada. Ezrin sigue usando coros sesenteros, pero le imprime ciertas atmosferas de terror. Hay que escucharla algunas veces para apreciarla debidamente, muy bien hecha.
One Nigth Stand, Post Punk que recuerda mucho Bauhaus a Joy Division y un poco, a lo lejos, a los subvaluados The Stooges. En momentos, la voz de Alice es irreconocible al cantar de una forma muy distinta a como lo conocemos. Chulada.
Blood on the Sun. Una barbaridad. Una pieza de Ópera Rock magistral, que sin lugar a dudas, se cuela entre las mejores de toda la carrera de Alice. Una obra de arte de principio a fin. Crap That Gets in the Way. Muy bien lograda, aunque hay partes con mucho ADN de The Kinks. Famous Face suena más a un hard rock ochentero, suena a la época de finales de los ochentas de Alice, muy al sonido de finales de los ochentas. Money Screams Punk Glam de alta manufactura donde Ezrin vuelve a hacer uso de coros típicos de Bubblegum rock de los años 60s. Muy bien lograda.
What a Syd. Glam rock puro que recuerda a Iggy Pop, a ciertas cosas de Lou Reed y que, al menos a mí, si me gustó mucho. Intergalactic Vagabound Blues. Es un Boogie-blues que en momentos recuerda a Three Souls in My Mind, y en el que Alice, vuelve a tomar la harmónica y Denis nos obsequia una catedra de bajo. What Happened. Banjos, piano, tiene una base rocanrolera. Cumple, pero de alguna forma creo que sale sobrando en el álbum. I Aint Done wrong, unos wha-whas pacheconoes dan inicio a un blucesito bien armado y que cierra la obra entre armónicas. Qué bien tocan estos señores, madre mía!
See you on the other side. Una power ballad muy al estilo de Alice en su etapa de finales de los años ochenta y mediados de los noventa. Muy buena pero creo que fuera de lugar en un disco cuya intención, según entiendo, es la de la etapa de la Alice Cooper Band y no en su trabajo como solista.
Este inesperado, y contra todo pronóstico regreso, representa una bocanada de oxígeno en una escena musical marcada por la falta de propuestas artísticas, el uso del auto-tune y la estupidez como premisa, donde la banda da muestra de estar a la altura de cualquiera de sus producciones anteriores y Bob Ezrin, una vez más, da muestra de su genialidad al conseguir una producción con el sonido inconfundible de los años setentas, pero con un enfoque actual en la producción, que le da frescura al conseguir un acabado moderno. Larga vida a Alice Cooper!
8.5/10

UN IDIOTA LLAMADO ROGER WATERS
Por: El Chamuco González
No quise dejar pasar por alto las últimas 2 declaraciones, (muy desafortunadas y reveladoras, por cierto), del otrora co-fundador y líder de Pink Floyd, Roger Waters. Solo en de esta semana, a Don Rogelio se le ocurrió, primero, salir a defender con una vehemencia que raya en lo ridículo, y una ignorancia que escandaliza, al narco-dictador-asesino de Nicolás Maduro. Según Rogelio, el cártel de los soles, el tren de Aragua y otras linduras más, son solo un montaje creado por Estados Unidos para apoderarse de los dinosaurios en forma líquida de Venezuela. Hace un llamado a los “hermanos y hermanas Venezolan@s”, a resistir y mantener el legado bolivariano y la memoria intocada del simio de Hugo Chávez. Por Dios y la santa virgen!!
Activista de ocasión, este idiota, al defender (desde la comodidad de su mansión y la seguridad que le brinda su fortuna de más de 310 millones de dólares) a un asesino que lidera un narco-estado, se burla de todo un país sumido en una crisis humanitaria sin precedentes, lo que me parece no solo estúpido, sino hasta de cierta forma, siniestro y criminal. Porque no deja sus palacios y se va a Caracas a defender, como causa de vida, la causa bolivariana? Maldito criminal.
Este viejo decrepito no es otra cosa que un pícaro burguesillo, su lengua es de izquierda y su cartera de derecha. Pareciera a alguno de esos religiosillos que comen santos y escupen demonios.
Pues bien, todavía no terminaba de enfriarse el cuerpo de Ozzy Osbourne, cuando este imbécil, víctima de incontinencia verbal y diarrea mental, un par de días después de apoyar al simio de Nicolás Maduro, se burló y se expresó de la manera más irrespetuosa, injusta y cobarde, tanto del Príncipe de las Tinieblas, como de Black Sabbath, en una entrevista concedida al medio Independent Ink. Fuera de lugar, poco humano, muy ofensivo y de muy mal gusto.
Nada tardó el hijo del Príncipe, Jack Osbourne, en salir a defender la horna de su padre y mandó, como todo hijo debía hacerlo, a “mingar a su chadre” a Rogelio. Eres buen chico, Jack.
Siempre me ha desconcertado la razón por la cual a algunos artistas les da por hacerle al “activista”, por no decirlo de otra forma. Que paso con U2? Desde el momento en el que al mamón de su cantante (un tipo petulante llamado Bono que utiliza unas insoportables gafas amarillas), le dio por hacerle al activista, su carrera se vino abajo, al igual que la de sus compañeros. Pero que chistoso, no? Colabora con organizaciones no gubernamentales en programas de lucha contra el hambre en África, y a pesar de tener una fortuna que asciende a los 700 millones de dólares, no aporta un solo centavo para combatirla de verdad, no solamente de saliva.
Algo similar pasa con este idiota, quién a falta de una nueva propuesta artística trascendente, como las que tuvo en un lejanísimo pasado, su ego y su necesidad insaciable de atención, lo llevan a cometer este tipo de yerros. Ya siéntese señora, dice el meme. Para algunos, estas líneas podrán ser irrespetuosas, para otras, incendiarias y para unos más, justas. Sea cual sea, a mi me tiene sin cuidado lo que piensen. Yo aquí escribo lo que pienso, y siempre he creído que el artista debe hacer arte sin más. Hágase político si quiere, hágase activista si le da la gana, o artista si se le hinchan las amígdalas, pero no mezcle las cosas porque el público piensa de las formas más diversas inimaginables y lo único que consigue es mancillar su arte y perder adeptos.
Roger Waters tiene una carrera como pocas en el mundo del rock. Soy amante de la música de Pink Floyd, pero no adorador de ídolos de barro. Disfruto muchísimo de obras como Piper of Gates of Down, Meddle, Obscured by Clouds, Dark Side Of The Moon, pero de ahí para acá, poco, muy poco, es lo que ha aportado. Amused to Death y Radio Kaos son buenas obras. El experimental Music From the Body me parece muy interesante, pero… De eso ya pasaron más de 35 años y el señor nomás no sale del ultra-achicharrado The Wall en sus conciertos. Ya chole con The Wall. Tuvo el atrevimiento de componer una ópera basada en la Revolución Francesa, llamado Ca Ira, y como amante de la Ópera, puedo afirmar que es una obra coral, sosa, larga y sin mayor aporte.
El rockersillo de medio cachete debe ser cauto y saber distinguir al artista de la persona, y no venerar ídolos de barro. Sin ser psicólogo o psiquiatra, creo que las capacidades cognitivas de Rogelio están intocadas a pesar de tener 80 años de edad. No creo que sea demencia senil o algo similar, ya que se ve muy lúcido, más bien es una envidia que lo corroe de ver como el mundo entero lloró por la partida de Ozzy Osbourne, cuando a él, día a día, el mundo mismo lo va olvidando más y más. Y respecto de su apoyo a Nicolás Maduro y su “causa”, una muestra clara de que es un perfecto imbécil.
La Foto
Por azares del destino, me tocó recibir en un hangar privado del Aeropuerto Internacional de Toluca, el vuelo privado en el que arribó a Roger Waters a México, un día antes de su concierto. Lo recibimos 3 personas sobre la plataforma de la escalinata dispuesta para descender del avión.
Después de abrirse la puerta de la aeronave, (nueva, enorme y muy lujosa, por lo que alcancé a ver), descendió una mujer mayor acompañada de una adolecente. A los pocos segundos, asomó su cara una sobrecargo de apariencia hindú y dio paso a que apareciera Rogelio. Después de saludarle, y antes de bajar por la escalinata, me percaté que estaba desorientado, acabado de despertar. Le pedí que me firmara 3 portadas de vinilos. Los elegidos fueron el Oscured by Clouds, Ummagumma y The Wall. Los firmó de buena gana, o eso percibí. Aprovechando el momento, le pregunté si le incomodaba que me tomara una fotografía con él (realmente fueron 2), y al acceder a mi petición, al acercarme, me llamó la atención que la fragancia que expedía Don Rogelio no era la más agradable. Pareciera que no se había bañado en varios días. Eran casi la una de la mañana y hacía frio. Al bajar las escalinatas, antes de entrar a una de las Suburbans, Rogelio le reclamó a la sobrecargo, de forma muy grosera, y con malas palabras, el hecho de no haber sido despertado 20 minutos antes del aterrizaje y no después del mismo, lo que me dejó muy mal sabor de boca, tanto a mí, como a las pocas personas que pudimos atestiguarlo. Ahora comprendo perfectamente porque Gilmour, Manson, y Wright lo mandaron al carajo. Por mamón y por ególatra. Che viejillo bolsas meadas…
Nota Aclaratoria
En alguna ocasión, al mostrarle a mi mujer las fotos que me he tomado con bandas legendarias de rockandroll (más de 40), así como las anécdotas de los encuentros, me comentó que le parecía algo de mal gusto tomarse fotos con los artistas. Eso me hizo sentir mal de una forma u otra, pues quizá tenga razón. Sin embargo, aquellos que somos coleccionistas de vinilos o de memorabilia relacionada con el maravilloso y fascinante mundo del rock, sabemos que un disco firmado puede llegar a valer más de 100 veces o más, que uno sin firmar. Y no existe mejor certificado de autenticidad, que una fotografía, y si en la misma se observan los artículos firmados, mejor.
Nunca he vendido, ni venderé jamás, ninguno de las portadas o backstages que me han firmado, son mi pequeño tesoro. Lo que si he hecho, es el intercambiar. Al igual que los niños de 12 años intercambiaban tazos, también los niños de 50 años, intercambiamos, pero discos. En mi caso jamás en la vida he idolatrado a nada ni a nadie, ni terrenal ni celestial, y no hay mejor muestra de ello que este artículo.
P.D. Another Brick in The Wall me parece insoportable.
Comentarios: [email protected]
Agur

CORROSION OF CONFORMITY. Próximo concierto en el Paso
Por: Chamuco
Con 42 años de carrera artística al lomo, recios, necios y aguerridos, Corrosion of Conformity es una banda que ha dejado una huella indeleble e innegable en la historia de la música.
En su largo andar, evolucionaron del más crudo hardcore-punk al Crossover-Trash Metal (quienes junto a D.R.I. crearon el género), para posteriormente ir mutando al Metal Alternativo, Sludge-Metal, Stoner Metal y terminar en algo inclasificable, de mucha riqueza artística que amalgama todo lo anterior, con una buena dosis de Black Sabbath y rock sureño de buena cepa.
Desconocida por muchos, la banda nació con un adn muy peculiar, diferente a la gran mayoría de las bandas.
Gozan de esa bella cualidad estoica que pocas bandas pueden jactarse de tener: Rompen el molde con el cual están diseñadas la gran mayoría de los grupos. Su propuesta no va dirigida a las masas, no fue pensada para el rockersillo de medio cachete.
Por increíble que parezca, aún existen, por fortuna, artistas que no están dispuestos a sacrificar su arte a cambio del éxito comercial. Por citar ejemplos, aunque disímbolos, tenemos a Voivod, Fantômas, o Sleep, entre algunos otros.
Los aferrados de Corrosion, no han gozado, ni gozarán, de fama ni de fortuna. Sin embargo, su propuesta artística, a pesar de transitar por una profunda metamorfosis, permanece pura, inmaculada. Y eso se admira, se respeta, y principalmente, se disfruta.
Actualmente se conforman por el gran Peepper Keenan en las vocales y guitarra, Jason Petersson en la batería, Bobbie Landgraf en el bajo y Woody Weatherman en guitarra.
A lo largo de su trayectoria, han publicado 10 álbumes de estudio, donde su desarrollo musical va develándose ante el escucha como cambiante y continuo.
De su basta discografía, destaca Blind (1991), álbum que se aleja del sonido Hardcore-Punk/Crossover-Trash Metal de sus primeros 2 discos, para explorar nuevos horizontes con elementos de Sludge y Stoner Metal. “These Shrouded Temples”, “Damned For Alll Time” y “Buried”, sobresalen de este gran trabajo. Ahí le va el enlace por si le apetece escucharlo:
https://youtube.com/playlist?list=PL4B651E973B24129C&si=eEuPsWvt_JhZGwpH
De igual forma, Deliverance (1994), su siguiente maqueta, continua con ese proceso evolutivo, lo que resulta en una obra que decide despojarse completamente de sus raíces para adentrarse en algo más lento, más pesado. Stoner Metal de alta manufactura. Sin duda, uno de los referentes del género.
Cuenta con texturas que recuerdan a ZZ Top, Lynyrd Skynyrd, o .38 Special. Aunque todo el disco es una joya, destacan “Albatros” y “Clean my Wounds”. Ahí le va este otro, píquele:
https://youtube.com/playlist?list=PLFC5A02B39E35CC19&si=-KGkmEKX0NIcs1ga
Como dato al margen, es importante mencionar que Peepper Keennan, formó, junto a Phil Anselmo de Pantera, el super grupo Down. Así mismo, la amistad de Keennan con James Hetfield, se ha vista reflejada en la colaboración de Peeper con Metallica en el cover de Lynard Skynard “Tusdays Gones”, y a su vez, James Hetfield en “Man or Ash” del álbum Wiseblood de Corrosion of Conformity.
Pues bien, para aquellos que tengan planeado ir a comprar calzones al Ross, Corrosion of Conformity podría ser una excelente opción si quiere escuchar una banda legendaria, que, sin tanta fama, ni tanto rollo, nos enseñan como se hace rock del bueno.
CORROSION OF CONFORMITY
21 de octubre de 2025
Roadhouse Bar and Grill
9828 Montana Ave El Paso, Tx 79925
Mayores de 18 años
7:00 pm
Tickets: 30 dólares

Tool. Lateralus (2001)
La obra matemática de Tool.
Por: Chamuco
1.- Intro
Para poder abordar correctamente este álbum, es preciso, antes que nada, dar un poco de contexto a manera de introducción. Solo así, será posible comprender, dimensionar, y disfrutar, principalmente, esta obra de arte.
Hay álbumes que marcaron un hito en la historia de la música. Ese tipo de álbumes (que no se ven muy a menudo), marcaron un antes, y un después. Influenciaron notoriamente a otras bandas y abrieron nuevos horizontes. Hoy hablaremos, aunque sea muy por encimita, de una de esas obras.
Sin embargo, antes de hacerlo, es necesario hacer la distinción entre lo que es un álbum “común”, y un álbum “conceptual”, ya que posiblemente alguno de mis 3 lectoras y/o lectores, desconocen de ello y abría que empezar por ahí.
Un álbum “común”, es aquel que se compone de varios temas que no tienen relación alguna entre sí, sea temática o musicalmente. Vaya, son aquellos que se conforman por piezas aisladas sin tener en común un hilo conductor y/o concepto cohesivo.
A su vez, un álbum conceptual, será aquel, en el que sus temas o canciones, están relacionadas temáticamente entre sí, generando con ello, una obra conformada por todas las canciones que la componen, permitiendo así, un espectro más amplio, artísticamente hablando.
Al ser reproducidas en su totalidad, con una coherencia temática entre sí, permite al compositor crear historias más elaboradas, más completas y más descriptivas, obsequiando al escucha, una experiencia más completa, de aquella que pudiera obtener con la reproducción de un álbum convencional.
La invención de los discos conceptuales se la debemos a los 4 fabulosos, Los Beatles (quienes más podrían ser?), cuando el 26 de mayo de 1967, los monarcas tuvieron a bien publicar el inmortal Sergent Pepper Lonely Heart Club Band. Casi nada, jeje.
El álbum, narra la historia de una banda ficticia (¿su alter-ego?) que ofrece un concierto. Fue tal el impacto, (era lógico que sucediera), que, con el paso del tiempo, otros grupos elevaran sus pretensiones artísticas, y replicaron el modelo, logrando en la gran mayoría de los casos, obras maestras de la música.
Nacieron así, obras de gran calado, como Lamb Lies Down on Broadway de Genesis (1974), Trick as a Brick de Jethro Tull (1972), Operation Midcrime de Queensryche (1998), Metropolis Pt. 2: Scenes From A Memory de Dream Theater (1999), The Wall de Pink Floyd, 2112 de Rush, (que ya se reseñó en esta humilde columna), y Tommy (1975) de The Who, por citar solo algunos.
2.- Tool
La banda, que vio la luz en una California de principios de los noventas, convulsa, cambiante e incierta para la escena rockera, desde un inicio mostraba signos de que no encajar o sonar en la misma sintonía que las demás bandas de la escena. Tenían otra intención artística, no andaban en el mismo viaje. Sus coetáneos se decantaban más por el rock alternativo y el naciente grunge.
Tool desde un inicio, mostró tendencias más enfocadas al Art Rock y el Rock experimental.
Compuesta por un ex diseñador de interiores llamado Maynard James Keenan en la voz, un ocultista consumado llamado Dany Carey en los tambores (¿el mejor baterista del mundo actualmente?), el técnico de efectos especiales holliwoodense Adam Jones en la guitarra y Paul D´Amour, un bajista que ya se había forjado por aquellos entonces, un nombre como músico.
En ese lugar y en ese momento, (1990), la banda publicó su primer demo 72826, que en el teclado telefónico corresponde a la palabra Satán, lo que generó una enorme controversia, jajaja.
Undertow (1993), en el que, aunque se trata de un disco medio de rock alternativo, ya se desprenden ciertos matices de lo que en un futuro sería su sonido y estilo inconfundibles, único, con piezas como Prision Sex y Sober.
Para 1996, publican su segundo álbum titulado Aenima, y a partir de ahí, es cuando la banda llama la atención a nivel mundial. En esta nueva entrega, deja la banda en términos amistosos el bajista Paul D´Amour (actual bajista de otra bandota, Ministry), y toma su posición Justin Chancellor.
El álbum, no solamente fue el producto de la evolución y madurez de su propuesta artística, sino que sirvió, en una especie de metamorfosis musical, para fraguar lo que posteriormente se terminaríamos identificando como el “sonido Tool”, y por añadidura, la consolidación también, de un nuevo subgénero dentro del mágico mundo del metal, llamado Progressive Metal, el cual venía gestándose con bandas como Fates Warning, Dream Theater y Queensryche, sin embargo, este álbum lo llevó a otro nivel.
Después de 5 años de silencio tras la publicación de Aenima, el 18 de mayo de 2001, por fin vio la luz su siguiente trabajo. Lateralus. En términos de maternidad podríamos definirlo como parto con dolor. Me explico. Después de la salida de Aenima, la banda pasó por un periodo de oscuridad debido a problemas legales con su casa disquera, la infame Volcano Records, quienes los habían demandado por un supuesto incumplimiento de contrato.
Al mismo tiempo, un fulano llamado Ted Gardner, quién había fungido como manager de la banda, les había demandado de igual forma, pero por un supuesto falta de pago.
Los problemas no dejaban concentrarse a la banda en la composición de su nuevo material, y, por el contrario, les generaba muchísima frustración. Así, en esa vorágine de negatividad y de caos, es cuando por fin, sale a la luz...
Lateralus, cuyo título hace referencia al pensamiento lateral (una forma de resolver problemas de forma distinta a la convencional, haciendo uso de la creatividad en contraste con la forma lineal o convencional), representó no solamente una obra de arte monumental, sino que, a su vez, se trató de un suceso comercial sin precedentes, contra todo pronóstico, desbancando en la lista de Billboard a artistas de la talla de Madonna, Jay-Z, Eminem, entre muchos otros.
Alcanzó el puesto número 1 al vender más de medio millón de copias en menos de una semana, algo inusitado en una banda de metal progresivo.
A partir ese momento, los rockersillos de medio cachete, advirtieron que aquello no era un disco común. Estaban ante algo que no se ve a diario, algo monumental. Aparecieron hordas de fanáticos, que, fascinados por el halo de misterio que rodeaba a la banda desde sus inicios (no daban entrevistas y su comportamiento arriba del escenario era, por decir lo menos, enigmático), trataban de comprender y descifrar los enigmas ocultos, que, según ellos, había (¿o hay?), en sus canciones.
Como comentario al margen, hay que decir que, hoy en día, ALGUNOS de esos fanáticos (no solo los de Tool, sino del metal progresivo) son insoportables. Tienden a percibirse a sí mismos como intelectuales y no merecedores de música más simple, más terrenal. Creen haber alcanzado el nirvana en ese subgénero.
Llegué a escuchar de un amigo mío, (a quien le profesó cariño y respeto, y por lo mismo, no revelo su identidad), quien es amante del metal progresivo, referirse a este subgénero como “música inteligente, para gente inteligente”. ¡VAYA MAMARRACHADA, POR DIOS SANTO! JAJAJAJAJA.
En Lateralus, aparte de su majestuosidad musical, el arte visual es igualmente genial. Corrió a cargo del gran artista plástico Alex Gray, cuyas ilustraciones psicodélicas de la anatomía humana, sin piel, a musculo vil, alude, de alguna forma, a la conexión del ser humano entre su cuerpo, mente y alma, haciendo acentos en algunos de los chakras.
Representa, visualmente, y de manera magistral, el ADN del concepto del álbum: el crecimiento interior.
3.- Matemáticas al servicio del Arte
No es fácil, en tan poco espacio, ni con conocimientos matemáticos tan limitados como los míos (si no pude entenderle al libro de Baldor), poder explicar decentemente la parte matemática de la obra, pero al menos lo intentaré. A ver...
Los antiguos griegos, entre otros muchos aportes a la matemática, descubrieron que había un rectángulo, al cual, si trazaban en su interior un cuadro, quedaba un rectángulo más pequeño, el cual, a su vez, sorprendentemente tenía las mismas proporciones que el rectángulo original.
Descubrieron a su vez, que dicho rectángulo, tenía muchas aplicaciones, y representaba lo que llamaron la proporción áurea.
Pero, ¿qué es? Podríamos definirla como la representación matemática de la armonía, el balance y la belleza. ¿Su representación numérica? El número 1.61803, también conocido como el número de Dios.
En la naturaleza, está presente en todas las espirales de la naturaleza, la distribución de nuestra galaxia, en muchas de las proporciones y estructuras del cuerpo humano, las olas del mar, el número de pétalos de algunas flores, el número de espirales en las piñas de los pinos, etc, etc.
En la arquitectura, podemos citar las pirámides de Gyza en Egipto, la Catedral de Notre Dame en París, el Taj Majal de la India, entre otros casos.
En la pintura, la proporción áurea está presente en la Mona Lisa de Leonardo Da Vinci, El Nacimiento de Venus de Sandro Boticelli, etc.
En la música, por su parte, la encontramos en parte dela obra de Mozart, en la de Bach (Johann Sebastián, no el patarato de Sebastián, el ex-vocalista de Skid Row), así como en la del grandísimo compositor académico-avant-garde de origen húngaro, Béla Bartók (uno de mis compositores favoritos del siglo XX, por cierto). Y en más reciente data, en Lateralus de Tool.
En nuestra vida cotidiana, vemos ese rectángulo al que hacemos mención en las tarjetas de crédito o identificaciones, las maquinas hace-pendejos, también llamadas pantallas de televisión, por citar solo un par de ejemplos.
Pasarían pues, muchos años del descubrimiento de dicho rectángulo y de su aplicación en nuestra vida, para que, en la edad media, el matemático más reconocido de sus tiempos, un tal Leonardo de Pisa, también conocido como Fibonacci, inventara una fórmula matemática, conocida como la secuencia de Fibonacci, la cual es una serie de números, donde cada número, es la suma de sus dos anteriores, comenzando con el 0 y el 1. De tal forma, que la secuencia inicia de la siguiente manera: 0, 1, 1, 2, 3, 5, 8, 13, 21 ,24, 34, 55, 89, 144, 233, 377, 610, 897, 1597, etc, etc
Otro ejemplo, seria:
(0+1=1), (1+1=2), (1+2=3), (3+2=5), (5+3=8), etc, etc.
La banda, a pesar de que jamás hizo público el hecho de haber utilizado dicha fórmula en su proceso compositivo, los fanáticos, matemáticos muchos de ellos, lograron identificar muchos elementos o patrones que demuestran su aplicación en la totalidad de la obra, no solo en Lateralus como afirman erróneamente algunos.
El álbum inicia con el sonido de lo que parece ser el encendido de un proyector cinematográfico, como preludio para el viaje que estamos próximos a vivir. Vaya viaje. Al terminar el sonido del proyector, cuya duración es tan solo de unos segundos, da inicio...
1.- The Grudge. El álbum inicia con el sonido de lo que parece ser el encendido de un proyector cinematográfico, como preludio para el viaje que estamos próximos a vivir. Vaya viaje. Al terminar el sonido del proyector, cuya duración es tan solo de unos segundos, da inicio...
Cualquier rockersillo de medio cachete identifica a la banda desde el primer segundo.
Literalmente. Es inconfundible el sonido Tool. La letra trata de cómo nos afectan aquellas vivencias o recuerdos negativos, rencorosos, mostrándonos como única solución para poder seguir creciendo espiritualmente, es mediante el perdón y el cierre definitivo de todos aquellos círculos negativos.
El grito de Maynard, en la parte final de la canción, es desgarrador. Son 23 segundos de catarsis que transmite un dolor y una frustración profundamente conmovedora. La piel se nos pone chinita al escucharla, vaya.
A pesar de ser la primera pieza del álbum, se encuentra unida a la última canción, como veremos más adelante.
2.- Eon Blue Apocalypse. Es un interludio compuesto por Adam Jones en memoria de su mascota llamada Eon Blue, quién por aquellos ayeres, estiró la pata. Literalmente. Ad-hoc para dar pie a la siguiente pieza.
3.- The Patient. Lleva una fuerte carga emocional. Está inspirada en la madre de Keenan, quién durante más de 29 años estuvo postrada en una cama, víctima de una parálisis parcial ocasionada por un aneurisma cerebral.
La letra, es una alegoría vista desde la perspectiva de su madre, quién se cuestiona su martirio, animándose así misma a no rendirse, ser paciente y aguantar su dolor, con la esperanza de una futura recompensa divina, ya que quizá, ese era el destino que tenía Dios trazado para ella.
Una pieza fuerte, pesada (no solo musicalmente), emocional y muy conmovedora.
Este mismo tópico, el martirio de la madre de Maynard, Judith Marie Keenan, sería el alma del siguiente álbum de la banda, titulado 10,000 Days, haciendo referencia precisamente, al número de días que tuvo que estar postrada antes de morir).
4.- Mantra. Una pieza de música electroacústica, resultado de la grabación del sonido emitido por el gato de Maynard (mientras éste lo abraza), para posteriormente modificarlo mediante el uso de la tecnología.
5.- Schism. Como su nombre lo dice, habla de un cisma, una ruptura dentro un grupo de personas que pertenecen a una misma organización o agrupación. La falta de comunicación conlleva al quiebre, al final. Muchas personas lo malinterpretan al pensar que trata de la disolución de una pareja por falta de comunicación, sin embargo, lo anterior es completamente falso, ya que en realidad trata de la frustración y el dolor que representaron los problemas legales con su antigua casa disquera, Volcano Records. Quiere ver de qué trata más o menos el viaje de esta banda? No sea necio, píquele aquí:
https://www.youtube.com/watch?v=MM62wjLrgmA&list=RDMM62wjLrgmA&start_radio=1
6.- Parabol. Una introducción hipnótica que da una base sonora para recibir la voz de Keenan, aderezada de atmósferas sonoras que incluyen el uso del Didgeridoo, un peculiar instrumento antiguo de origen australiano.
Por momentos, la atmosfera adquiere tintes de música árabe. Keenan canta acerca de la importancia humana como una fase intermedia del ser, antes de alcanzar un nivel superior de conciencia.
Transformación, crecimiento. Sirve de interludio perfecto para la siguiente pieza… ¡ufa marufa, que cosa!
7.- Parabola. Nos recuerda que el dolor, sea físico o emocional, no es más que una ilusión, y que la vida humana es solo una experiencia temporal antes de alcanzar otro plano superior. Nos invita a disfrutar de la oportunidad que nos brinda la vida de estar aquí, respirando. Vivos.
El video oficial, es dirigido por Adam Jones, quién ya tenía harta experiencia en stopmotion y artes visuales. Jones participó incluso, en la elaboración de efectos especiales en las películas Jurassic Park, Caza fantasmas, y algunas del fredicugar, entre muchas otras.
Píquele al enlace, querida lectora, apreciable lector, es toda una exquisitez audiovisual. Pura gozadera. Hágame caso. Ahí le va: https://www.youtube.com/watch?v=-_nQhGR0K8M&list=RD-_nQhGR0K8M&start_radio=1
8.-Ticks and Leeches. Desde el inicio del tema, se percibe con intensidad, la rabia y la frustración.
La letra describe, metafóricamente hablando, como se sintieron abusados por su entorno, primero su casa disquera y luego su antiguo manager.
Pocas veces es tocada en vivo debido a la dificultad y riesgo que representa el desgaste en las cuerdas vocales de Maynard. Uno de sus gritos cuales tiene casi un minuto de duración. Captura perfectamente el estado anímico de la banda en ese momento. ¿Musicalmente? Una salvajada.
Pareciera que Dany Carey tuviera un cerebro en cada una de sus extremidades. Una locura.
9.- Lateralus. Originalmente la llamaron 987. Su estructura musical, están basada en la espiral de Fibonacci. En el estribillo, se dan cambios de compases que pasan del 9/8, al 8/8 y al 7/8, respectivamente, dando como resultado 987, el decimosexto número de la secuencia de Fibonacci.
Las letras siguen la misma secuencia, ya que la métrica silábica de la misma, lleva ese mismo orden matemático. Primero, de manera ascendente:
Black (1)
Then (1)
White Are (2)
All i see (3)
In my Infancy (5)
Red and Yellow the come to be (8)
Reaching out to me (5)
Let´s me see(3)
Posteriormente, continúa bajo la misma directriz, pero de manera descendente:
As below so avoe and beyond I image (13)
Drawn beyond the lines of reason (8)
Push the envelope (5)
Watch it bend (3)
OJO: No se cuentan las palabras, sino las silabas dentro de las mismas.
Existe también un dato curioso que vale la pena comentar. La voz de Maynard, comienza justo en el minuto 1.37 segundos, lo que vendría a ser 1.618 minutos, también conocido como phi ó número áureo, mismo que mencionamos al principio de este artículo.
En la medida que avanza la secuencia, la proporción entre dos números consecutivos se acerca cada vez más al número áureo. Puedes incluso dividir cualquier numero de la secuencia de Fibonacci por el número anterior, y verás que el resultado se acerca siempre al 1.618.
También, en la letra de la canción, menciona en repetidas ocasiones la palabra espiral (¿acaso la de Fibonacci?), y cierra repitiendo 4 veces:
Sipral out, Keep going (Espiral, sigue adelante), haciendo claramente alusión a la espiral de Fibonacci.
Coincidencias? Jajaja De ninguna manera.
10.- Reflection. No ha sido una, ni dos veces. Desde que escuché por primera vez este disco, al escuchar este tema no puedo evitar recordar a Dead Can Dance. Los primeros minutos del tema pareciera que se trata de los australianos y no de Tool. El uso de la tabla hindú y de otras percusiones orientales proporciona un aire de misticismo sublime, en el que el protagonista se cuestiona su existencia, su conexión con el cosmos, y su necesidad de desprenderse del ego para alcanzar un plano superior. Viajada, introspectiva, y densa.
11.- Triad. Similar al tema anterior, esta pieza tiene en sus primeros minutos algunos elementos de música árabe y bases rítmicas africanas.
12.- Dispositions. El que el protagonista reflexiona acerca del cambio, de la mutación espiritual. La repetición de las frases “Watch the weather change” y “Mention this to me” hacen, a pesar de su simpleza, una lírica profunda y coherente con el resto del álbum.
Disposition, Reflection y Triad, en conjunto y en ese orden, se les conoce como la santa trinidad.
13.- Faaip de Oaid. Podría traducirse al castellano como “La voz de Dios” en enoquiano, un supuesto lenguaje revelado por lo ángeles al antiguo alquimista y ocultista inglés Edward Kelley, allá por el lejano siglo XVI.
Es importante resaltar la fuerte influencia del misticismo en la banda. Dany Carey es un consumado ocultista, y férreo practicante de a Thelema, una corriente filosófica-religiosa formada por Aliester Crowley, cuya esencia podría resumirse en “haz tu voluntad”.
Así mismo, existen innumerables ejemplos, tanto en canciones, como en letras, y en símbolos plasmados en la batería y el escenario, en los que se hace referencia a la geometría sagrada, la alquimia y el ocultismo.
Están a la vista, están a la escucha, solo hay que saber observar, saber escuchar..
Faaip de Oaid es una pieza extrañamente aterradora, y adorable al mismo tiempo.
Un poco de contexto: La leyenda dice que la madrugada del 11 de septiembre de 1997, se recibió una llamada telefónica en el programa “Coast to Coast”, un popular show radiofónico, que, aunque se transmitía desde Nevada, tenía cobertura nacional.
Su conductor fue Art Bell, un locutor de fama nacional. La temática del programa giraba en torno a eventos paranormales, vida extraterrestre y temas relacionados con teorías de la conspiración.
Vaya, algo así como la mano peluda, pero en versión gabacha. Un mausancito pero güerito.
La cosa, fue que, quién llamó esa madrugada, era tipo que se escuchaba alterado, excitado, en pánico, y quién afirmaba haber trabajado en el Área 51. El fulano aseguraba tener información clasificada, de esa que en las películas ochenteras se encontraba dentro de un sobre con la leyenda TOP SECRET, y la cual, aseguraba, estaba relacionada con un supuesto plan que tenían, por una parte, las altas esferas del gobierno de los Estados Unidos, y por otra, una civilización extraterrestre. Esa supuesta alianza buscaría tomar el control de la población mundial, al costo que fuera. Sin embargo, después de hablar durante algunos minutos al aire, al ir cobrando coherencia poco a poco todo lo que afirmaba, la estación dejó de transmitir durante poco más de 30 minutos a nivel nacional.
El mito dice que gobierno acudió a la estación de radio, para confiscar las cintas respaldo. Tool rescató parte de las grabaciones (algunas radioescuchas grabaron parte de la trasmisión y la banda hizo uso de las mismas para utilizarlas en esta pieza), para hacer de ellas un lienzo sobre el que plasmaron una obra experimental muy densa, cuyo resultado final fue extraordinario, pero al menos, para quién escribe estas líneas, incomprensible. No sé que trataron de decir o cual es su mensaje. Al día de hoy la disfruto mucho, pero creo que es mas debido a un gusto adquirido que a otra cosa.
4.- El orden correcto.
Anteriormente, cuando se grababa en discos de vinilo, también conocidos como LP´s, el espacio en “blanco” para grabar, se encontraba limitado a 22 minutos por lado (ya muy pujadito), lo cual representaba todo un reto, tanto para la producción, como para la casa disquera. Con la llegada del disco compacto, esa problemática desapareció.
Como dijimos anteriormente, desde la publicación del disco, los tool-fans dedicados al mundo de las matemáticas, empezaron a analizarlo. Sin embargo, cuando salió la versión en vinilo de Lateralus, (donde el orden de las canciones no es el mismo que el del disco compacto), en una entrevista, la banda comentó que aunque preferían el orden del disco compacto, el orden de la obra no es ninguno de los publicados, el del cd y el de lp. Eso provocó que la raza enloqueciera aún más, y siguieran analizando el disco, descubriendo cosas demás sorprendentes.
Lograron descubrir, aparentemente, 2 formas o secuencias, mediante las cuales, el disco, si cambian el orden de las canciones y quitamos el sonido de pausa entre canción y canción, se logra escuchar al álbum como una sola pieza completa, sin cortes, donde encajan los ritmos y los compases, sincronizados, con lógica, con coherencia musical.
La primera conocida como Lateralus Prophecy , propone la reproducción siguiendo este orden:
6,7,5,8,4,9,3,10,2,11,1,12,13
La segunda, y más aceptada, es la conocida como The Holy Gift:
6,7,5,8,47,9,13,1,12,2,11,3,10
En esta última se inicia con la pieza final (13) en el medio, con la intención de unir el comienzo (The Grudge), con el final Faaip de Oaid. A título personal no lo he escuchado todo el álbum, pero lo poco que escuché, suena sintonizado y coherente. La verdad es una obra de arte única. No he escuchado algo similar en toda mi vida. Y aclaro, no soy de esa fauna Tooliana de fans que los ven como seres superiores, ni mucho menos. Lo digo desde la objetividad.
Lateralus, más que un disco más de metal progresivo, pareciera que es la grabación del sonido de una pieza de relojería de alta gama, en el que se registra el sonido de muchísimos engranes trabajando a ritmos y compases distintos, para crear en su conjunto, algo perfecto y de una complejidad musical asombrosa.
Deseo agregar que yo disfruto el disco en youtube, ya que no lo tengo en cd ni en vinilo. Parte de la reproducción sugerida en el Holy Gift me tocó escucharla una mañana de sábado en el Tianguis Cultural del Chopo, pero no me he clavado, ni me clavaré en analizar la obra.
Yo escucho música para disfrutar, no para entenderla. Sin embargo, para aquellos que quieran investigar más al respecto, hay muchos foros en internet (principalmente en inglés), que estudian hasta el detalle más mínimo relacionado con este disco. Al grado de la obsesión.
Mejor disfrútelo y no se claven en la textura como mucho rokersillo de medio cachete.
Calificación: 9.5/10
Por último, quisiera aprovechar la ocasión para dar gracias a un conejo llamado Quick, alias de José Luis Campos, quién es un gran músico experimental, y escuchador de cosas poco ortodoxas, y tuvo a bien, allá en los primeros años de la década de los 2000´s, compartir esta obra conmigo.
Comentarios: [email protected]

Robert Plant. Un hombre muy ocupado/Concierto
Eran las 7 de la mañana del 13 de marzo de 2015. Yo estaba solo, sentado en una de las mesas del Restaurante Diana del exclusivo Hotel St. Regis, frente a una taza de café. Llevaba encima una resaca que parecían dos, y tanto el día como la noche, pintaban para largo. Ese mismo día, pero por la noche, se celebraría el primer día del Festival Vive Latino 2015.
En dicha edición, se presentaron “joyitas” de la talla de Babasónicos, La Lupita, Aterciopelados, Caifanes y Molotov.
Sin embargo, dentro de tanta paja (por no decir otra cosa), había entreverado un diamante. La asistencia era obligada para cualquier rockersillo de medio cachete.
Robert Plant, vocalista de Led Zeppelin, regresaba una vez más a la Ciudad de México. Esta vez, con su nueva banda, Robert Plant and the Sensational Space Shifters.
Debido a que por x o por y razón yo tenía conocimiento de que Roberto Plantas se había hospedado en dicho hotel y desayunaría muy temprano en el Restaurante Diana (que se encuentra dentro del hotel), acudí al lugar desde las 7 de la mañana con la esperanza de poder saludar a una de mis mayores influencias musicales de todos los tiempos, y aprovechar de paso, jeje, conseguir su firma en 3 portadas de cd´s de Led Zeppelin.
Llevaba conmigo, la de de su primer álbum, homónimo de la banda, así como las del Physical Graffitti y Presence, respectivamente. Las 3 de cd. Imposible intentar hacerlo con portadas de vinilo de 12 pulgadas, debido a que hubiera sido descubierto al instante. La seguridad de dicho hotel, es quizá la más estricta y cerrada de todos en los que se hospedan bandas de ese nivel. (Si no pregúntenle a Nicko McBrain cuando no le permitieron ahí mismo en el St. Regis la entrada al ser confundido con un indigente jajaja). Hizo un panchote de antología, por cierto.
Después de varias tazas de café y casi dos horas de espera, tome la decisión de que si en 10 minutos más, no aparecía Roberto en el lugar, era hora de retirarse. Ya habían bajado a desayunar algunos miembros de su banda y nada. Pasó el tiempo estipulado y pedí y pagué la cuenta dispuesto a retirarme. Para poder salir del hotel, es preciso, al salir del restaurante, recorrer un pasillo de unos 20 metros antes de llegar a la salida. Al ir recorriendo ese pasillo para irme, por fin apareció Don Roberto en camiseta blanca, pantalón de mezclilla, y unas botas vaqueras desgastadas. Caminaba hacía mi, venía solo y cargaba consigo un libro y unos lentes de aumento.
Ya chingué, me dije a mi mismo, al estar a unos pasos de él, saqué de mi saco las 3 pequeñas portadas. Al ver las portadas, y sin haberle dicho aún nada, me dijo que iba a desayunar, que si quería lo esperara y me firmaría las portadas. De momento me sentí avergonzado por haberlo importunado y también un poco estúpido, pero si ya había esperado 2 horas y tenía su palabra de que me firmaría mis portadas, me valió poquita madre, dejé mi ego a un lado y me dispuse a esperarlo. Ya no fueron dos horas de espera pero si 45 minutos más.
Todo ese tiempo yo estuve sentado en unos sillones que se encuentran al lado de un bar, sin perder nunca de vista la única entrada-salida del restaurante, por lo que cuando vi que salió (nuevamente solo), procedí a abordarlo. Desde el primer momento me impresionó la humildad de este Señor. Lo primero que me dijo al volvernos a encontrar fue que lo disculpara, pero que llevaba mucha hambre al bajar. La verdad no supe que contestarle y me pidió las portadas de los cds y ahí mismo me las firmó. Al entregármelas, le pregunté que si podíamos tomarnos una fotografía y accedió de muy buena forma. Un mesero que se dirigía al restaurante fue quién me ayudó, pues no había nada de gente en el pasillo. Después de tomarnos las fotografías, me preguntó que si qué más podía hacer por mí. Era algo surrealista para mí lo que estaba pasando. Y pues bueno, ya sobre la barra y con el brazo caliente, aproveché la oportunidad y le dije que si me firmaba unos autógrafos para mi hijo y un par de amigos me haría muy feliz, a lo que me respondió con una sonrisa: No Problem.
Debido a que no llevaba conmigo hojas de papel para que las firmara, y ambos debíamos forzosamente recorrer el pasillo que da hacía la salida, a la recepción del hotel, así como al ingreso a la zona de habitaciones, le pregunté que si no tenía problema en que pidiéramos unas hojas en la recepción para que las firmara.
Al ir recorriendo esos 20 metros aproximadamente, no supe que decirle y me quedé callado. Pasaron pocos segundos en silencio, cuando, casi al llegar a la recepción, me preguntó que porque si había estado esperándolo mientras desayunaba, ahora que estaba con él no hablaba. Solo atiné a decirle que para mí era algo increíble ir caminando prácticamente a solas con una de las leyendas más grandes del rock de toda la historia. Se me quedó viendo y respondió que no, que él solo era un hombre muy ocupado. Mientras caminábamos, tuve el atrevimiento de preguntarle qué tanto de realidad y que tanto de mito, fue un hecho que sucedió a bordo del Starship (su avión-mansión). Sin embargo, no me respondió nada, y aunque sonrió, me quedé con la impresión que le incomodó la pregunta. Ni modo, quién les manda ser tan desmadrosos jajaja.
Llegamos a la recepción y me firmó 4 hojas tamaño carta dedicadas a las personas que mencioné anteriormente. Después de hacerlo, volvió a preguntarme si podía hacer algo más por mí. Solo extendí mi mano y le dije muchas gracias.
Lo más bizarro de todo es que esas hojas las metí en un folder y duraron en mi vehículo unos días. Hasta que lo llevé a lavar y seguramente los tiraron pensando que eran basura.. JAJAJAJAJAJAJAJA.
Por azares del destino, he tenido la oportunidad de conocer (y en algunos casos conbeber) con muchas bandas de rock a nivel internacional, y puedo decir, sin lugar a dudas, que Robert Plant es el más sencillo y humilde que haya conocido. Por mucho. Hay mucho artista que se siente tocado por la mano de Dios, por decirlo de alguna forma. Algunos de bandas internacionales, pero también otros de bandas nacionales y también locales, sin embargo, solo son simples payasos con problemas de ego.
EL CONCIERTO
12 horas más tarde de haber saludado a Plant, tuve la oportunidad de escucharlo cantar en vivo. Ya lo había escuchado cuando en aquel lejano 1995, se presentó en el Palacio de los Deportes al lado de Jimmy Page. Conciertazo. Habían pasado muchos años ya, y quería constatar el estado de su voz, 30 años después. El concierto inició con Babe, I´m Gonna Leave You, una de las canciones más emblemáticas de Led Zeppelin, que sin embargo, pocos saben que es un cover de la maestra Joan Baez. Desde los primeros acordes el público se rindió ante el maestro. Me sorprendió la calidad, potencia y tesitura de su voz. A pesar de ser un hombre mayor, su calidad vocal es impecable. La banda que lo acompañó, definitivamente no son Page, Bonham, ni Jones, pero son grandes músicos. Digo, no creo que Plant se plante (jeje) en un escenario con cualquiera. El show continuó con algunos covers de blues como Fixin´to Die de Bukka White y No Place to Go de Howlin´Wolf. De Led Zeppelin cantó Black Dog, Going to California, What Is and What Should Never Be, Whole Lotta Love y, después de abandonar unos minutos el escenario, regresaron parea cerrar la noche con Rock and Roll. Un día y una noche memorable para mi Así pasó la cosa. Comentarios: [email protected]

Melvins/napalm death en concierto. Reseña
Por: Chamuco
En días pasados se llevó a cabo un concierto de las bandas Weedeater, Dark Sky Burial, Melvins y Napalm Death. La cita fue en el Lowbrow Palace, un foro que se ha convertido en todo un referente para la escena de música alternativa e independiente en la ciudad de El Paso, Texas. El costo del boleto fue de 25 dólares, una chulada si lo comparamos con los precios de acá, y más si tomamos en cuenta que es por un evento que trae 2 bandas legendarias, algo que se ve muy pocas veces.
De las primeras dos bandas no tengo nada que decir, puesto que nunca las he escuchado y mi intención fue únicamente ver a Melvins (principalmente) y a Napalm Death.
Para dar un poco de contexto a quienes no los conocen, Melvins es una banda de culto que lleva en actividad desde los años ochenta. Se les atribuye ser los inventores del Sludge Metal (un subgénero derivado del Doom Metal con influencias de Hardcore-Punk), y haber sido una influencia muy importante para el nacimiento del Grunge. Pero ojo, no es una banda de grunge. Nada que ver. Su música es compleja, a veces lenta y pesada, otras veces, rápida y agresiva, con tintes experimentales, y siempre pacheca, muy pacheca.
La banda la conforman Buzz Osbourne “King Buzzo” (guitarra y voz), Dale Crover (batería) y Steve “Shane” McDonald (bajo). En sus presentaciones en vivo usan dos bateristas, por lo que el encargado del otro set de tambores es Coady Wills.
A diferencia de aquellas bandas a quienes influenciaron y crearon lo que después conoceríamos como el Grunge, Melvins apostó por dejar inmaculada su propuesta artística y no contaminarla con elementos pop para alcanzar la fama.
Criminalmente subvaluados, su obra es buenísima por decir lo menos, y a pesar de ser poco conocidos fuera del mundillo de la música experimental o de vanguardia, lo menos que puede decirse de ellos, es que, aparte de virtuosos, su propuesta artística es única (sin parecido alguno a otra banda), y su influencia dentro de la historia de la música es innegable.
Como dato anecdótico es importante señalar que Kurt Cobain, al ser amigo de King Buzzo y gran fan de Melvins, trabajó como ayudante de la banda durante algún tiempo. Posteriormente colaboró en la producción de su icónico disco Houdini, para mí, uno de los mejores discos de los años noventa.
Regresando al concierto, llegué tarde al lugar (para variar), y Melvins ya estaba arriba del escenario.
En 1995 o 1996 tuve la oportunidad de verlos en el Festival Lollapalooza en Phoenix, Arizona, y me dejaron impactado, por lo que mis expectativas de esa noche eran enormes.
Al ingresar al lugar hay un pequeño recibidor con una barra al lado izquierdo. Está bien equipada con 3 cantineros dispuestos a calmar la sed del respetable a cambio de 6 dólares la birrita, y a 9 los pistos. Frente a la barra, dejando casi todo el espacio del recibidor, instalaron mesas con discos de vinilo y playeras de las bandas a la venta. (La nueva forma de sobrevivir de las bandas).
Al lado izquierdo del recibidor hay una gran puerta que da entrada al foro propiamente dicho. Los Melvins tocaban arriba del escenario, sobresaliendo principalmente la imagen de la cabellera inconfundible del Rey Buzzo (parecida a la de quién sufre la explosión de un boiler) y lo primero que me llamó la atención fue ver que nadie estaba grabando con su teléfono celular el concierto.
Eso me dio un buen sabor de boca. El público de esa noche era distinto al que comúnmente se ve en la mayoría de los conciertos, donde la gente idiota, sí, idiota, se distrae grabando videos pedorros, perdiéndose así la oportunidad irrepetible de disfrutar el evento, y lo peor de todo es que muchas de las veces lo hacen con el afán de presumir en redes sociales que ahí andaban de argüenderos. O.. miento? Jajaja, che raza..
Pues bien, ya estando ahí en el güateque, a diferencia de los conciertos que se celebran en el DF, o aquí en Chihuahua (pero en menor medida), donde el tratar de colarse al frente del escenario se convierte en toda una odisea y requiere el uso de técnicas parecidas a la lucha grecorromana (y lo digo literalmente), allá, por el contrario, la raza no se apasiona tanto, por lo que pude colarme hasta enfrente y sin problema alguno, en menos de 2 minutos.
Ya instalado, el simple hecho de ver tocar a una banda frente con a dos baterías pegadas entre sí (los hi-hats de una bateria están situados del lado derecho y los hi-hats de la otra están del lado izquierdo), generan lo que se conoce visualmente como efecto espejo, nos dice que no se trata de una banda común y corriente.
A pesar de no llegar desde el inició del concierto, pude presenciar la mayoría de su chou, en el que demostraron una técnica impresionante fueron respaldados por un sonido impecable que no presentó falla alguna en todo el evento.
De su repertorio puede decirse que fue bien seleccionado. Never Say You´re Sorry, Honey Bucket, Blood Witch, A History of a Bad Man, Billy Fish, Revolve y Your Blessened son algunas de canciones que dieron un pequeño repaso por su larga trayectoria con mas de 20 álbumes de estudio en su haber. La realidad de las cosas disfruté muchísimo de su presentación y cumplieron a cabalidad con mis expectativas. Extraordinaria banda. Mis respetos.
Al terminar su presentación, y mientras cambiaban las baterías e instrumentos de Melvins para dar inicio a la presentación de Napalm Death, procedí a salir afuera del lugar a fumarme un cigarrillo y esperar sin estar rodeado de tanta gente a mi alrededor. Afuera del recinto habría unas 10 o 15 personas. Algunas fumaban y conversaban entre sí, y algunas otras hablaban por teléfono.
De Napalm Death lo menos que puede decirse es que al igual que Melvins, son legendarios y su aporte al Metal es enrome. Considerados los creadores del Grindcore y influencia fundamental del Death Metal, la banda originaria de Inglaterra mezcló el hardcore-punk con el metal, obteniendo así algo extremo nunca antes escuchado. Uno de sus antiguos guitarristas Bill Steer abandonó la banda en 1989 para formar Carcass. Actualmente se encuentra conformada por Mark “Barney” Greenway (voz), Shane Embury (bajo), Mitch Harris (guitarra) y Dany Herrera (batería). Dentro de sus gracias esta la de tener la canción mas corta de toda la historia según el Libro de los Records de Guinnes, ya que You Suffer tiene una duración de 1.316 segundos de duración, jajaja. ¿Su música? Deambula entre el Grindocre y Death Metal, pero también en el Art Rock y el Avant-Garde.
Yo seguía fumando y que sobre una de las calles al lado del Lowbrow Palace se encontraba estacionado un camión de pasajeros enorme de color negro con el motor encendido, pero no me llamó la atención.
Al paso de unos minutos, al probar los amplificadores de Napalm, quienes estaban ya a punto de subir al escenario, hizo que las personas que se encontraban al exterior del lugar, ingresaran a buscar su lugar para disfrutar de la siguiente banda. Yo decidí quedarme afuera a esperar que empezara realmente la presentación, cuando vi abrirse la puerta del camión que se encontraba estacionado y descender del mismo a Mark “Barney” Greenway, con quién tuve la oportunidad de conversar por un lapso de 2 o 3 minutos ahí afuera antes de ingresar al lugar. Debo decir que Barney, aparte de sencillo, es una persona muy agradable y educada. (se anexa foto).
Una vez que se despidió e ingresó al lugar, al paso de unos minutos dio inició la presentación y decidí entrar. Al igual que con Melvins, la gente se dedicó a disfrutar del concierto sin grabarlo, muy pocos (contados) estaban bebiendo y no vi a nadie fumar. Embury es el que se ve mas cansado de todos, y sin embargo, dejó el alma sobre el escenario como los grandes. Los movimientos sobre el escenario de Barney, y su vestimenta de esa noche, me recordó el origen Anarkopunk de la banda (con gran influencia de Crass). De principio a fin, dieron catedra de lo que es la brutalidad y el metal extremo.
De su repertorio de esa noche destaca Multinational Corporations, Amoral, Social Sterility, Scum, You Suffer, Prision Without Walls, así como un cover de los grandísimos Dead Kennedys “Nazi Punks Fuck Off”. Me había tocado verlos en algún festival, pero nunca les había puesto bien atención en vivo y me llevé una grata sorpresa, al comprender, ahora sí, de que trata la banda. Así pasó.
Comentarios: [email protected]

La mujer en el rock. Segunda parte
Por: Chamuco González.
Yoko Ono. Sin duda alguna, es la artista musical más odiada en el planeta tierra. El simple hecho de escuchar su nombre, genera urticaria, asco, coraje, y en algunos casos, odio. Hágame usted el chingado favor.
Es verdad que fue la gota que derramó el vaso y adelantó la ruptura de los Beatles (que ya era casi imposible que pudieran llegar a seguir juntos, incluso desde mucho tiempo atrás de la llegada de Yoko. También es cierto que mucho de su arte es chocante y desagradable, pero arte al final de cuentas.
Como olvidar su desafortunada participación en el show de Mike Douglas, donde Lennon, al interpretar Memphis Tennesse junto a su héroe Chuck Berry (el verdadero rey del rock and roll), permitió que su mujer tomara un micrófono y emitira unos berridos dignos de lepe chiple en supermercado.
Chuck, atónito y fúrico, no supo cómo actuar ante semejante mamarrachada y decidió no detenerse y continuar tocando. En un acto de lucidez, el ingeniero de sonido desconectó el micrófono de Yoko. Una cosa espeluznante, sin embargo, creo que la culpa fue de Lennon, jajajaja.
Debemos partir que hay música arte, y música entretenimiento. No es lo mismo la música de Karlheinz Stockhausen, Gyorgy Ligeti, Iannis Xenakis (música académica) o Ghedalia Tazartes (Avant-Garde), a la de Beatles, Stones o Scorpions. Los primeros que mencioné, serán incomprensibles y posiblemente ruidos sin sentido para la mayoría de las personas, mientras que los segundos, serán de mas fácil digestión musical, siendo así mucho más probable que obtengan el gusto de la gente.
Lo mismo pasa con ella. Su arte es experimental, encasillado (si cabe la expresión), en el poco conocido y menos comprendido género llamado Avant-Garde. Que sea incomprensible para algunos no significa que no sea bueno. En gustos se rompen géneros, no?
Pues bien, resulta que la maestraza desde antes de conocer a Lennon, tenía ya una carrera artística tanto en el performance como en otras monerías. Una vez al lado de Lennon incursionó en la música, y tuvo a bien acercar la música experimental y el Avant-Garde con el rock y música popular. Que tiene discos malos? Si. Que todos los son? No, claro que no.
Con 92 años al lomo, acaba de publicar en este 2025 el álbum “Selected Recordings from Grapefruit by Yoko Ono”. Aynomás.
Algo habrá visto en ella Lennon, no cree usted? Déjese de prejuicios baratos y odios estériles, disfrute este par de álbumes, uno de ella como solista y otro de Plastic Ono Band, con John Lennon.
https://www.youtube.com/watch?v=je_0emt7bPI&list=PLpD8yubKML8y6F6hcbaWo286aQJwUUSkx
https://www.youtube.com/watch?v=DzQy-EsNfuM&list=PLiN-7mukU_REIkMJiBC7SheVd4KKSOaF4&index=2
Janis Joplin. De la bruja cósmica debo escribir un artículo completo. Sin embargo, no podía bajo ningún motivo dejarla fuera dejarla fuera. Pues bien, de Janis hay que empezar diciendo que fue la primera estrella de rock femenina. Aclaro, no es la primera mujer rockera, pero si la primera rockstar.
Perseguida por sus inseguridades, y presa de una vida insoportable en su ciudad natal, el destino la llevó a San Francisco en pleno auge del movimiento hippie, que tuvo a bien dar a luz en la intersección de las calles Haight y Ashbury. Una banda llamada de rock psicodélico llamada Big Brother and the Holding Company la adicionó y obtuvo el puesto al instante.
Su voz era muy bella y muy potente. Mucho. Su voz podía transitar desde los susurros más suaves hasta los gritos mas desgarradores y dramáticos. Una fuera de serie.
Durante muchos ha sido descrita por muchos como la única mujer blanca que puede cantar como una mujer negra, lo anterior, a manera de halago. Famosa por la cantidad de alcohol que podía llegar a ingerir la muñeca.
Era cliente asidua a un restaurante bar llamado Barney´s Beanery donde agarraba sus guarapetas, siempre en la misma mesa, con un chamaco llamado Jim Morrison. Hace algunos años, tuve la oportunidad de echarme algunas cervezas en esa mesa para honrar la memoria de ese par.
Janis, que le pegaba duro al whiskey Southern Confort, se dio cuenta que en muchas de las fotografías que le tomaban, siempre aparecía con una botella en mano de Southern. Juntó muchas de ellas y fue a hablar con la compañía para decirles que les estaba haciendo publicidad por lo que consiguió un patrocinio. Jajaja. Posiblemente sea el primer caso de un patrocinio brindado a una estrella de rock. Su participación el festival de Woodstock la catapultó al estrellato y más allá. Única. Irrepetible.
https://www.youtube.com/watch?v=SCngPse1iiI&list=RDSCngPse1iiI&start_radio=1
https://www.youtube.com/watch?v=7gsqBEPSrd0&list=RD7gsqBEPSrd0&start_radio=1
The Runaways. A mediados de los años setentas, unas adolecentes (casi niñas), formaron una banda de rock. Un productor de la época llamado Kim Fowley, vio una oportunidad de oro en ellas y se encargó de forjar su nueva propuesta musical, la cual, estaba seguro, tendría éxito.
Joan Jett, Lita Ford, Sandy West, Jackie Fox y Cherrie Currie hacían un hard rock-punk siendo todavía adolecentes. Tuvieron un éxito comercial mediano en Estados Unidos, logrando mayor penetración en Japón, donde llegaron a grabar un álbum en vivo.
La historia de Kim es la misma de muchos managers. Abusó (y robó) de muchas formas a estas adolecentes. Con el paso del tiempo las diferencias artísticas no tardaron en causar la disolución de la banda. Mientras la música de Joan Jett era más punk, la de Lita se inclinaba más al heavy metal. Cada quién hizo su carrera en solitario y ambas tuvieron mucho éxito.
Si no las conoce, píquele al enlace, hágame caso.
https://www.youtube.com/watch?v=HYxUAeEs8mE&list=RDHYxUAeEs8mE&start_radio=1
https://www.youtube.com/watch?v=_EBvXpjudf8&list=RD_EBvXpjudf8&start_radio=1
PJ Harvey. Es difícil hacer una descripción breve de esta gran artista. Su obra es vasta y prolífica. Intencionalmente, sus trabajos son completamente distintos entre si.
Deambula entre el art rock, el alternativo alternativo, rock experimental e indie rock. En el año 2013, por su aportación a la música de Inglaterra, fue nombrada por la Reina Isabel II como miembro de la orden del imperio británico. Una gran artista. https://www.youtube.com/watch?v=STxXS5lLunE&list=RDEMop0eKg-43F0Tc3mHoHJRtQ&start_radio=1
Contacto: [email protected]

La mujer en el rock. Primera Parte
Por: Chamuco González
Desde tiempos inmemorables, triste e injustamente el papel de la mujer dentro de la sociedad (machista) ha sido minimizado a grado tal, que la misma fue invisible prácticamente en todas las actividades, incluyendo las artes.
El Rock siempre fue algo “reservado” a los hombres. Siempre se trató de un “club de Toby” en el que las damas no tenían cabida. Supuestamente ellas no tenían la capacidad de crear rocanrol…. Hasta que brincó la primera aguerrida... y de ahí pal´ real. Aunque es irrelevante el orden en el cual voy a mencionar a algunas de tantas mujeres que forman parte de la historia musical y contribuyeron enormemente a la creación y evolución del rock en todas sus variantes, sirvan estas líneas a guisa de reconocimiento a su obra. La mayoría de quienes en estos días vamos a mencionar superan fácilmente a muuuuchas bandas consagradas conformadas por hombres. ¿O…miento?.
No es adulación barata, nomás lo que marca la aguja dijeran por ai.
1.- Wendy O. Williams. No sé si sea la mejor, pero si la que más me gusta. Ella entró al club de Toby (sí, ese conformado únicamente por hombres) y no llegó tocando la puerta. Entró derribándola de una patada y mentando madres. Se ganó el respeto al instante. Después de haber trabajado como mesera, cocinera y bailarina exótica, incursionó en el cine para adultos, donde en alguna de sus películas, ¡¡¡expulsó pelotas de ping-pong!!!! ¡Maestra! JAJAJA.
En el año de 1977, junto con Rod Swenson, formó la banda de heavy metal-punk The Plasmatics, (una banda de culto muy poco conocida pero muy muy grande). Sus shows incluían la explosión de un vehículo en el escenario, escopetazos a los amplificadores, la destrucción de televisores a martillazos, así como la destrucción de guitarras a motosierra. Vaya, la Wendy no se andaba con minucias. Las apariencias engañan y en el caso de la ella, no es la excepción. A pesar de que su actitud y aspecto arriba del escenario era disruptivo y transgresor, (senos al aire y peinado mohawk), en su vida privada era completamente distinta, tranquila, más en sus últimos años.
Siempre estuvo muy comprometida con las causas ambientales, el respeto a los animales (que no es lo mismo), el vegetarianismo y la alimentación saludable. Era activista, no de saliva, de acciones.
Con Plasmatics grabó discos memorables (diferentes entre sí) los cuales me parecen muy difíciles de describir con palabras. No sé qué estilo de música sea sinceramente. Es ecléctica. Algo parecido a Heavy Metal con Punk.
En 1984 Gene Simmons (Kiss), vio el potencial de la muchacha, y al ver que no salía del circuito subterráneo con los Plasmatics (obvio, lo menos que buscaban era ser igual a los demás), la convence para entrar al estudio y grabar WOW (Wendy O. Williams), su álbum debut como solista.
Cuando escuché este disco por primera vez, (gracias a mi amigo el Ingeniero Raúl Tovar), algo me llamó la atención desde el primer momento. No sonaba a Plasmatics, sonaba a Kiss. Sabía (a instancias del Inge), que el álbum había sido producido por el repugnoso de Gene, y comprendí así, porque el álbum sonaba mucho a Kiss.
Después de hurgar en la contraportada del vinilo, me llevé la sorpresa que no solo había sido producido por Gene, sino que también él grabó todas las líneas de bajo con el seudónimo de Reginald Van Helsing. Adicional a ello, también hay participaciones de Eric Carr, Ace Frehely, Paul Stanley, y Vinnie Vincent. Como que la respetaban poquito, no? Jeje.
Mi conclusión al terminar de escuchar el álbum es que WOW es un disco que suena mucho a Kiss, y que, sin ser de Kiss, es el mejor que grabó Kiss en toda esa década, jajaja. Miento? Nah!
Le guste a quien le guste. Esa es la verdad. Por ese álbum fue nominada al Grammy por la mejor interpretación femenina de rock en 1985.
En 1987 se gestó un último trabajo entre Wendy y Plasmatics. Maggots: The Record. Un álbum conceptual. La obra está basada 25 años en el futuro y narra la tragedia de una familia que, debido a la quema de petróleo y sus derivados, el planeta se encuentra en agonizando, conllevando a morir a cada uno de sus miembros en un lapso de 3 días.
En 1998, cansada de todo y de todos, Wendy decide irse a vivir al campo en compañía de Rod Swenson. Se asientan en Storrs, Connecticut, donde día a día la vida le parecía insoportable, debido a una profunda depresión que sufría. Llevaba 4 años hablando de quitarse la vida, por lo que a nadie sorprendió (mucho menos a Rod), el enterarse de que, lamentablemente, se había suicidado.
*Como dato curioso, un personaje de Mario Bros llamada Wendy O. Koopa está basado en la mera mera Reyna del Shock Rock. Lo duda? Juzgue usted mism@:
https://youtu.be/696zfH0OytM?si=I5e9Oz4YpzNfV9nA
https://youtu.be/CkLrlKveqZs?si=JAq420FUC8qlUD27
2.- Las Mary Jets. Unos de los casos más tristes e injustos que he conocido. Ni más ni menos se trata de la primera banda de rock femenina de la historia a nivel mundial. Fue una banda orgullosamente mexicana y nació en 1958 en la ciudad de México. Eran unas jovencitas de 17 y 18 años, estudiantes del Conservatorio Nacional de Música.
Originalmente llamadas como “Quinteto Frenesí”, decidieron cambiar su nombre a Las Mary Jets (ya que la mayoría se llamaban María) siguiendo el consejo de Enrique Guzmán. Según algunas entrevistas a sus integrantes, refieren que desde un inicio era casi imposible abrirse paso en la escena por la una y mil trabas que les ponían para que dejaran de tocar. (Había mucha envidia de las bandas del momento ya que no podían ejecutar sus instrumentos con la maestría y precisión con la que lo hacían estas chamacas.
Un elemento importante para mantener viva la banda fue su manager-protector-consejero-amigo llamado Cuco Valtierra. El final del grupo se dio por un coctel de circunstancias. La primera fue que la casa disquera con la que estaban en ese momento, se negó a publicar su segundo álbum debido a que nadie creería que esa música tan bien tocada la grabaron unas jovencitas. Que poquísima madre HDSPM.
La siguiente fue la muerte de su manager que era quién las mantenía unidas y les daba ánimo para no rendirse y seguir adelante.
La última fue que algunas de sus miembros tenían más interés en ser concertistas de música clásica que formar parte de una banda de rock. Les hicieron una y mil ingaderas para descarrilarlas hasta que lo lograron. Hay cosas que me reservaré porque creo que son de mal gusto publicarlas, fue muuuuuy triste y corriente lo que les hicieron a estas señoritas, grandes músicas todas ellas. También pienso que la el desconocimiento de su obra y la subvaloración de la misma por parte de aquellos pocos que la conocen es algo criminal.
https://youtu.be/Dljfp5-PqJ8?si=voEQTxW_ioqb6G6G
https://youtu.be/13wZ960tWeM?si=wVU16nBrnhQNUFx1
3.- Girlschool. Muy pocas cosas impresionaban a Lemmy Kilmister, pero estas chicas lo lograron al instante. Aún no grababan su primer álbum y éste tuvo a bien invitarlas a abrir los conciertos de Motorhead en la gira de su álbum Overkill en 1978. En 1980 publican su primer álbum Demolition, convirtiéndose así en la primera banda de Heavy Metal compuesta únicamente por mujeres, y de ahí pal´real. Su discografía abarca más de 15 discos de estudio y 3 álbumes en vivo. Bandota. P+iquele al enlace y compruébelo por usted mism@!.
https://youtu.be/BYNWo93fPG8?si=DL72linyF8Yt7RhN
https://youtu.be/WnJp-xA3lZ8?si=nv3SEaTAw3K9xomE
4.- Angela Gossow. Durante algunos años estuvo al frente de la banda sueca de Death Metal Melódico Arch Enemy, pero debido a una enfermedad en sus cuerdas vocales, tuvo que dar un paso al lado y recomendar a sus substituta Alissa White-Gluz. Este Angelito canta como demonio.
https://youtu.be/U9C2Vh1HMgc?si=utTiF4ayJWfYNK9D
Pd.- Saludos a Charlie Viz de la banda 41+1 por reportarse. Estamos pendientes.
Continuara…
Comentarios: [email protected]

El Metal en Chihuahua. Parte 3: Las Bandas
Por: Chamuco González
Antes de abordar el tema que hoy nos ocupa, es preciso señalar que los grupos que mencionaremos, son de Metal y no de Rock en general. No confundamos la magnesia con la gimnasia, vaya.
De igual forma, ofrezco una disculpa anticipada a las bandas que pudiera llegar a omitir. No fueron pocas y han pasado ya muchos años de que esto inició.
Mis comentarios no buscan hacer más o menos a nadie, por el contrario, este artículo es un homenaje a todas las bandas de Metal de nuestra amada ciudad; aunque nos constriñamos únicamente a sus primeras generaciones, de alguna forma es un gesto de gratitud a todas ellas por muchos momentos de gozo y diversión. Vamos pues...
De la primera generación de bandas que vieron la luz en esta, mi muy amada ciudad, Eskirla pudiese ser la banda que una gran parte del respetable considera la precursora del Metal. Lo anterior hay que tomarlo con reservas, ya que, más que Metal, bien podríamos encasillarlos dentro del hard rock y del blues rock.
Capitaneados por Rodolfo “El Soldado” Borja, Eskirla lleva desde 1980 dando guerra y por lo que parece, no hay intención alguna de claudicar. Hoy en día el encargado de los tambores es Alejandro Tirado, sin duda, uno de los mejores bateristas del norte del país.
Anubis encabeza la segunda generación (¿o primera?) de bandas de heavy metal chihuahuenses.
Allá por el año de 1987 ó 1988, siendo estudiante en primer grado de secundaria, cayó en mis manos un demo de ellos. Desde el primer momento en el que los escuché me gustaron y mucho. El trabajo consta de 8 o 10 temas (no lo recuerdo), dentro de los cuales se encuentra entreverada una baladita muy ad hoc a los álbumes de heavy de la época. Discazo de principio a fin. Mi favorito de heavy metal chihuahuense sin lugar a dudas.
Anubis estuvo conformado por Pepe Lugo (voz y guitarra), el gran Yen Lara (bajo) y Beto Ávila (batería).
Al ser mi grupo favorito de Chihuahua, quise escribir un artículo sobre su demo, sí, ese que había caído en mis manos en la primera etapa de mi adolescencia y del que ni siquiera sabía su nombre, aún y cuando recuerdo todavía la mayoría de sus letras.
Al no contar con la grabación para escucharla nuevamente y poder así escribir un artículo de la misma (rendierle homenaje), busqué un acercamiento a través de las redes sociales con uno de sus miembros. Vaya sorpresa que me llevé al darme cuenta que, aún después de pasado tanto tiempo, hay gente que sigue viviendo la lisérgica fábula de ser una estrella de rock.
Es cómico que personajes de la talla de Robert Plant de Led Zeppelin, Roger Waters de Pink Floyd, Rob Halfrod de Judas Priest o Steve Harris de Iron Maiden, entre muchos otros, hayan mostrado más humildad con este pobre aspirante a escribidor de rocanrol que un músico local a quién solo se le quiere homenajear su trabajo.
“Cada quien se emborracha con lo que quiere, chamuco” dijera mi amigo Juanito García en casos como este y tiene toda la razón el Emperador de Huejotitán. Adiós reseña.
Las charras con esos rockeros y muchos otros, las publicaremos próximamente, pero mientras tanto, sigamos con los Anubis.
Pues bien, de Anubis surgieron dos bandas: Tráfico y Viuda Negra. De Tráfico no tengo mucho que decir. Fue una banda de covers muy famosa en la ciudad que llegó a grabar a principios de los noventas una canción titulada “el abecedario”. Conformada por unos riffs duros sobre los cuales el vocalista deletreaba el abecedario en inglés “EI, BI, CI, DI, EI, ETC, ETC”. Eso era todo. No conocí otro material original de esta banda.
Por su parte Viuda Negra se decantó por componer y grabar música propia. En 1994, grabó su EP “Flotando en la Nada” en los estudios Crossroads en California. Aunque es un trabajo muy bien logrado, (en el que ya se nota la producción), me quedo con Anubis.
La segunda oleada (¿o la tercera?) fue mucho más abundante. Goetia (Miguel Orpinel, Leonel Pérez “La Loba”, Eddy Hinojos y el gran Miguel “Moco” García Q.E.P.D), fue una banda que, si bien la mayoría de su repertorio lo componían de covers, llegaron a componer música muy bien hecha con tintes de metal progresivo. Saludos a Micky donde quiera que se encuentre mi carnal.
Las Brujas Morrison, por su parte, más que una banda de metal, fueron un acto de reivindicación feminista. -No solo los hombres pueden hacer música agresiva- pareciera ser la premisa de las muchachas). Fue la primera banda de metal compuesta exclusivamente por mujeres en una época en la que la sociedad chihuahuense era mucho más machista y prejuiciosa que en la actualidad, lo cual era como gasolina para las Brujas Morrison. A pesar de ser un grupo de metal, su actitud rayaba más en el punk. Todo mi respeto Brujas!.
Perturbador (que posteriormente cambiaria su nombre a Dimensión) fue una banda originaria de la colonia Granjas que, según recuerdo, tocaban un batido compuesto por una mezcla de heavy-trash-progresivo. Buenísimos.
En un acto de superación artística, decidieron mudarse a la ciudad de Denver, Colorado, con la intención de grabar un disco y forjar así, una carrera artística en los yunaitedsteits.
Excelentísima banda, sin embargo, no se volvió a saber de ellos hasta el día de hoy.
Mortigena (comandada por Milton), es la banda que ha portado el estandarte del Death Metal en Chihuahua, al menos desde mediados de los noventas hasta la fecha, le guste a quién le guste. Muy buena banda. Su constancia es admirable.
Zagros Ática. Metal progresivo de alto pedorraje. Punto. Me ahorraré los comentarios para evitar caer en la subjetividad ya que los guitarristas fueron los mismos que tocaban en mi banda (Animalia) y a quienes guardo especial aprecio. (Abrazo fuerte para Lem-Kar y para Chino).
Letrina (Sabritón), Decidia, Abducted, Coventry, Mantra, Aneurisma, Legati, etc, etc, fueron, entre otras, algunas de las bandas que nos regalaron momentos de diversión, esparcimiento y desfogue a todos aquellos amantes de la “música del diablo” (dijeran las abuelitas).
Por último, una banda chihuahuense llamada Behold The Grave (Melodic Death Metal), después de ganar un concurso de batalla de bandas a nivel nacional, tuvieron el privilegio de presentarse en el Festival de Metal más importante del mundo: el mismísimo Waken Open Air Festival en la ciudad de Wacken, Alemania, donde tocaron en el año 2013.
No cualquiera. Aunque ya no es parte de su formación, durante algún tiempo estuvo el gran guitarrista Tori Lopéz. No me gusta para nada el género, pero Behold The Grave es un digno representante del mismo y orgullosamente es chihuahuense.
Faltan muchas bandas por mencionar, pero las anteriores podrían ser las más conocidas de la primera etapa del metal Chihuahuense. Una disculpa nuevamente para aquellas bandas que pude haber dejado de mencionar. Larga vida al Metal Chihuahuense!
Comentarios: [email protected]

El Metal en Chihuahua. Parte 2: Los Conciertos
Por: Chamuco González
Fue a finales de los años ochentas (¿87-88?) cuando se celebró el primer concierto de Metal en nuestra amada ciudad. Torture, una desconocida banda de Trash Metal originaria de El Paso, Texas, vino a tocar promocionando su EP Terror Kingdom. El evento se llevó a cabo el 14 de noviembre de 1987 en el Gimnasio Rodrigo M. Quevedo. A pesar de que no hubo mucha asistencia debido a la nula difusión del evento, el nivel mostrado por la banda arriba del escenario fue brutal, según comentan quienes asistieron, ya que no fue mi caso.
A pesar de las fallas de sonido y poca organización, la gente salió muy contenta. Es recordado como un gran concierto por quienes asistieron. En Youtube esta Terror Kingdom, una joya del underground trashero que vale mucho la pena escuchar.
Después de Torture, en 1991 vino Lizzy Borden en su gira del álbum Master of Disguise. El evento se llevó a cabo en el lugar donde se encontraba La Galatea (Tecnológico esquina con Juan Escutia) y fue el primer concierto de una banda de Metal conocida internacionalmente que pisaba Chihuahua.
Tampoco pude asistir, pero al parecer el evento tampoco tuvo una buena organización y el sonido dejó mucho que desear, sin embargo, y pese a ello, la gente salió feliz.
Tendríamos que sufrir 9 años de sequía para volver a tener otro evento en la ciudad. La estación de radio El Lobo trajo a Great White el 17 de noviembre de 1996 en el Estadio Almanza de la ciudad deportiva. La banda, que en ese momento promocionaba su álbum Let t Rock, contaba por aquellos entonces con algunos éxitos radiales y estaba presente en el gusto local.
Ese fue el primer concierto de metal realizado profesionalmente. El evento fue un éxito en todos los sentidos y dejó con buen sabor de boca tanto a los organizadores como a quienes asistimos.
Tres años más tarde, nuevamente El Lobo, organizó el LOBOFEST. El evento se llevó a cabo el 31 de octubre de 1999 en el Estadio Olímpico de la ciudad deportiva con la presencia de Slaugther, Firehouse y Warrant. Ay nomás. Hubo muy buena asistencia al festival y las 3 bandas tocaron muy bien.
Aunque el evento de Great White estuvo a la altura de una banda internacional, el LOBOFEST fue algo nunca antes visto en nuestra ciudad hasta ese momento. A partir de esos dos eventos organizados y financiados por EL Lobo, algunos promotores (locales y foráneos), vieron en Chihuahua una opción de negocio en el género metalero, y así, poco a poco empezaron a darse mas eventos.
A principios de los dosmiles empezaron a organizarse algunos conciertos en el hoy desaparecido Bar La Herradura (allá por Alimentos el Capitán de la salida a Delicias). Helloween, Stratovarius, Therion, Ángeles del Infierno, entre otros, llegaron a tocar en dicho lugar. A todos los que fui ahí me gustaron y también me divertí. El único inconveniente del lugar (aparte de los tránsitos, que ya andaban muy bravos desde aquellos entonces), era que los eventos se hacían en una especie de corrales al aire libre y como el piso era de tierra, ¡salíamos todos empanizados ja!
Poco tiempo después (¿o un poco de tiempo antes?) tocó Sepultura en el Patio Colonial (hoy el alsuper frente a la Cerve). Fue buen concierto, pero ya venían con Derrik Green. (desde la partida de Max Cavalera dejó de gustarme la banda).
Dio, Anthrax, Michael Schenker, Uli Jon Roth, Deep Purple, Dokken, Stryper, Kreator, Sodom, Carcass, Quiet Riot, Rata Blanca, Accept, Saxon, Amon Amarth, Rotting Christ, Ynwie Malmsteen, entre muchas otras que seguramente estoy olvidando, son algunas de las bandas que nos han visitado.
Mención especial merece la visita de Scorpions a Chihuahua el 22 de octubre de 2005 en el Estadio Monumental de Beisbol. Tampoco pude asistir (viví fuera de Chihuahua muchos años), pero me enteré fue un conciertazo. Fue lleno total (supuestamente se quedó gente afuera) y la producción dicen, fue espectacular.
Uno o dos años después, en una visita a la ciudad, al ir conduciendo mi vehículo, cambiaba constantemente de sintonización en la radio buscando algo que pudiera interesarme. Pasaban cumbias, norteñas, programas religiosos, noticias y.. trás! Scorpions salió al quite. Obviamente ya no seguí cambiando y más porque no se trataba de la insoportable Wind of Change.
Miré el tablero y me di cuenta que era D95. Se trataba de una grabación en vio. Inicialmente creí que se trataba del World Wide Live. Pero no. La calidad de grabación era profesional y se escuchaba crudo, sin producir.
Me llamó la atención que no cortaban el audio entre canción y canción, dejando algunos segundos de gritos y aplausos de la gente, sin recordar sinceramente si hubo o no, cortes publicitarios.
En esas estaba cuando al terminar una canción (no recuerdo cual), gritó el chaparro Meine al respetable: THENKIUUU SHIHUAHUAAAAAA!! De primer momento no comprendí, pero al primer segundo exclamé: “¡¡¡aaaaah cabroooooon!!!!!”.
Aunque no había tenido la oportunidad de asistir, tenía al menos la posibilidad, aunque fuera mínima, de escuchar el concierto si conseguía la grabación. Para ello busqué a Mauricio Estrada (quién me honra con su amistad y que), también conocido como “Furcio”, otro gran locutor de la ciudad a quién le pedí que me apoyara consiguiéndome el archivo de grabación. Políticamente correcto como es, se limitó a sonreír y responder: “Sí hermano, yo lo veo”.
De eso han pasado ya muchos años y cada que nos vemos, al insistirle con lo de la grabación, sonríe cínicamente y me repite lo mismo. Sinvergüenza. No he conocido a nadie que lo tenga o sepa de su existencia siquiera, pero la grabación existe y fue transmitida al aire. Dicho lo anterior, si alguno de mis pocos, pero muy apreciados lectores la llegasen a tener, le agradecería profundamente la gentileza de compartirla con su servidor.
Volviendo al tema jeje, actualmente el principal escenario para conciertos de Metal en la ciudad es sin lugar a dudas el Pistoleros House of Shows (allá por la Tecnológico, atrás de las instalaciones de la Guardia Nacional), y no de ahorita, sino desde ya bastantes años atrás. Varios de los conciertos que mencioné anteriormente, ahí se celebraron. Poco a poco el lugar ha venido mejorando y constantemente tienen conciertos de bandas nacionales e internacionales de diversos sub géneros dentro del Metal.
Korima grabación, Korima Scorpions, Kuira Ba!
PD: Olvidé en la entrega anterior en mencionar dentro de los bares a la Posada del Rey, el Cráneo y algunos otros. Una disculpa para todos.
Continuará..

El Metal en Chihuahua. Parte 1: Acceso a la música
Por: Chamuco González
FORMATO FISICO Y TIENDAS DE MÚSICA
La tecnología para la reproducción (y en algunos casos grabación) de música a principios de los años ochenta era reducida. No existían las maravillas modernas como las de hoy, en las que puedes llegar a tener un catalogo musical cuasi ilimitado con la simpleza de un “click” en tu teléfono móvil. Y no solo puedes acceder a audio, sino también video. Y si tienes computadora, puedes descargar discografías completas, bootlegs y grabaciones raras. (thepiratebay.org, por ejemplo).
En aquellos inicios de los años ochenta, contábamos con el rey de los formatos, nuestro amado disco de vinilo. Sin embargo éste, no nos permitía realizar grabaciones y requería de cuidados especiales para su manejo y reproducción. El formato 8-track iba ya de salida, y al igual que el disco de vinilo, tampoco permitía realizar grabaciones. El cassette por su parte, era el formato más popular, pues permitía realizar grabaciones de radio a cassette, vinilo a cassette y cassette a cassette.
Existían marcas como Maxell, TDK y los democráticos Memorex. Para mayor calidad nada mejor que los de cromo o de metal, aunque estos últimos, por ser más pesadas las cintas, lastimaban los carretes del deck.
Pues bien, el metalerillo chihuahuense de aquellos años, tenía las siguientes opciones para allegarse de música: O tenías la oportunidad de ir a El Paso y comprar material allá, o lo comprabas en alguna de las pocas tiendas que había en Chihuahua, o un amigo tuyo tenía un disco o cassette que te gustaba y te lo grababa, o lo comprabas grabado, o lo grababas de la radio, o .. jajaja. No había más. No había Spotify, ni Apple Music, ni cosas de esas.
En Chihuahua tuvimos establecimientos comerciales que se dedicaron a la venta de metal y de rock en general. Recuerdo Discomundo en Plaza Galerías. Un poco arriba sus precios, pero sin duda, para mí, fue la mejor tienda de música en Chihuahua. Discorama, ubicada en la calle Libertad, también en algún tiempo llegó a tener discos de rock. Nunca fue su fuerte, pero sí llegó a tener sus cosas. Musirama en su momento creo que llegó a tener, principalmente, cassettes. Melómano estuvo en la calle Ojinaga. Muuuy buenas cosas me tocó ver por ahí. Algunas cosas experimentales, fuera de lo común.
En el segundo piso de unos locales ubicados en la avenida Américas también había un local rockeroso. Tenían catálogos con cientos y cientos de discos (muchos de ellos de rock progresivo) que por una módica cantidad (tal vez unos 100 pesos actuales) te vendían la grabación en cassette de cromo, por lo que no lo hacía caro tomando el coste del cassette).
Sin embargo, de todas las tiendas habidas y por haber hay dos que destacan por mucho:
Rock Imports (a cargo de los Guilles) ahí sobre la Niños Héroes y Metal Shop (al mando de Luis Carlos Guerrero).
Según mis cálculos, ambas tiendas tienen más de 40 años de existencia metalera, y aunque han sufrido las de Caín, siguen y seguirán en pie.
Aunque Rock Imports de un tiempo para acá se enfocó más en la ropa y accesorios, sigue ofreciendo artículos rockerosos. Por su parte, Metal Shop, aunque vende ropa también, tiene mucha más oferta en cuanto a música se refiere (cd´s, vinilos, cassettes) y organiza, desde hace muchos años, viajes en autobús ida y vuelta para asistir a conciertos (me fui con ellos a ver a Pink Floyd en 1995). Ambas son igual de importantes y su aporte a la escena es el mismo.
LA RADIO Y MTV
Pues bien, en la radio de los años ochentas de nuestra amada ciudad, en frecuencia modulada (FM), existían únicamente 2 o 3 estaciones, las cuales transmitían música del tipo Ray Conniff, Richard Clayderman y artistas similares. Nada de interés para los radioescuchas jóvenes. Por su parte, en amplitud modulada, existían el 12.80, La Pantera y El Lobo, las cuales transmitían música pop y poco a poco dichas estaciones empezaron a programar rock.
Venía ya de salida la música disco que había pegado muy duro y daba paso poco a poco al rock ligero, que venía entrando con bandas como Police, The Cars, Queen, Journey, etc.
En aquel entonces, un chamaco de 15 ó 16 años llamado Charlie Contigo, alias Carlos Hoffman, jeje, quizá el locutor más famoso de Chihuahua, tuvo a bien programar (ya le daba a la cabina desde muy chavito), rock más pesadón. Al darse cuenta que al hacerlo recibía muchas llamadas de radioescuchas que preguntaban de quién era la canción que sonaba al aire, tuvo la genial idea (sí, genial) de crear un programa dedicado única y exclusivamente al Heavy Metal.
Así nació “La Hora del Hombre Lobo”, programa semanal, del que si no estoy equivocado, ya estaba al aire desde 1982. Recuerdo haberlo empezado a escuchar religiosamente todas las semanas (no recuerdo en que día se transmitía, y así lo hice durante muchos años.
El programa era un manantial de metal en el desierto. Mi catalogo era muy limitado en esa etapa temprana de mi niñez (se reducía a algunos 8 tracks y cassettes de mi tío), y en ese programa pude escuchar y conocer bandas nuevas. Toda la semana esperaba a que llegara el día de La Hora del Hombre Lobo para tener listo un cassette en el modular de mi Padre y oprimir al mismo tiempo el botón de REC y con el de PLAY, para capturar así, tan bella música que salía de los altavoces. Ya grabado, a darle vuelo toda la semana jeje. Fue muy buen programa, traía de todo, pero todo bueno.
Según mis cálculos, duró aire hasta 1994 cuando la estación migró a frecuencia modulada. Pasó del 10.10 del AM al 106.1 del FM. Una vez en frecuencia modulada, el programa cambió de nombre a Lobotomía. Fue la evolución de la La Hora del Hombre Lobo. No era lo mismo escucharla en FM. Qué diferencia, ahora podíamos escucharla en una calidad de audio muy superior a la del AM.
La programación de Lobotomía se había adaptó a los tiempos. No solo transmitían heavy metal ochentero y algunas cosas pesadas de los setentas, sino que ahora, también daban espacio en la programación a bandas emergentes que salían un poco del perfil musical que se venía transmitiendo en La Hora del Hombre Lobo. Ahora sonaban también Alice in Chains, White Zombie, Marilyn Manson, Pantera, Sepultura, etc.
Además, la estación rifaba, con dinámicas divertidas, conciertos con todos los gastos pagados. (Yo me gané uno a Lollapaluzza a Phoenix, Arizona en 1996 (Ramones, Melvins, Soundgarden, Rancid, Metallica), y otro en 1998 al DF (Pantera y Kiss).
La casa de enfrente, D-95 (quién acababa de llegar a la ciudad proveniente de Monterrey), quiso entrarle al ruedo y empezó a transmitir Distorsión, programa también de metal en el que participaban un par de locutores que comentaban novedades y las canciones que transmitían, pero… nomás no pudieron y sin pena ni gloria, más temprano que tarde, salieron del aire..
Pasarían unos años más hasta que Lobotomía llegó a su fin, pero no el compromiso de la estación con el metal. Hoy en día, y ya con muchos años al aire, se trasmite desde Nueva York, domingo a domingo, House of Hair. Conducido por el gran Dee Snider (vocalista de Twisted Sister), el programa está basado en piezas icónicas de Heavy Metal y una selección de muy buen gusto de Hair Metal. Muy recomendado. Domingos de 6 a 9 de la noche en el 106.1 del FM. No sé si exista, no solo en el norte, sino en el país entero, una estación que lleve transmitiendo durante tantos años programas de metal. Lo digo sinceramente. En otra entrega abordaré otro importante aporte de El Lobo a la difusión del heavy metal y el rock en general en Chihuahua.
Por otra parte, y en menor medida, el papel de MTV tuvo una relativa importancia en la difusión del heavy metal en Chihuahua. Muchas bandas de metal llegaron a grabar videos que se transmitieron en ese canal ya que el género había empezado a colarse dentro de la música pop, sin embargo, la cadena de videos estadounidense creó programas como Headbangers Ball (con el famoso presentador Adam Curry), y así, a través de la antena parabólica, muy comunes en la ciudad en los años ochentas, fue que se grabaron muchos videocasetes BETA o VHS y fueron distribuyéndose mano a mano. Conectabas dos reproductores de videocasete, en uno reproducías, en el otro grabas y listo.
BARES METALEROS
No es fácil hablar de bares de metal en la ciudad ya que hubieron algunos cuya existencia se limitó a una o dos tocadas. Pero dentro de los más conocidos estuvo el Cat House (una vieja casona sobre la avenida Colón casi esquina con la Niños Héroes). Era un lugar en franca decadencia cuyo menú se limitaba a caguamas Indio (cuando la indio pegaba, no como ahora) y donde toqué con mi banda allá por 1994.
Sin duda Don Burro (el de antes, cuando estaba al mando de mi amigo Elder García), también fue escenario por el que desfilaron muchas bandas de Heavy y de Trash. No fue uno ni dos, fueron varios años rockerosos los que nos regaló el bar.
De muy corta existencia, La casa del Poder tiene una mención especial. Más que un bar, era una experiencia surrealista. Diversión, mucha diversión, mucha cerveza y mucho metal. Quienes lo conocieron lo recordarán seguramente con alegría.
Café Concierto. Un tugurio ubicado en el segundo piso de un edificio casi enfrente de Soriana Niños Héroes. Toqué en dos ocasiones y en las dos hubo peleas. Los parroquianos del lugar eran seres semi salvajes, divertido pero pesadon el ambiente. Su menú era más amplio que en la mayoría de los bares de rock. Caguamas Indio… y también Carta Blanca!.
Jazz ¾. Fue un café-bar ubicado en la parte trasera de plaza cúpulas (frente al Sanborns del Ortiz Mena), en el que si bien es cierto que su ADN era Jazzístico, llegaron a darse algunos toquines de rock. (si estoy mal, corríjanme).
El Sold Out es un bar ubicado abajo del Hotel Soberano. He asistido un par de veces en fin de semana, y a pesar de ser pequeño, cuentan con un escenario en el que se presentan bandas de covers que tocan bien. No vas a escuchar Death metal o Trash metal, pero tienen buen rock.
Angels es quizá el lugar más conocido y el de más grande aforo en la ciudad. Inició sus operaciones hace ya varios años en la avenida Mirador casi esquina con Ortiz Mena y optaron por cambiarse a un lugar más amplio. Cuenta con un escenario y un equipo de audio de primer nivel y los fines de semana se presentan tributos y bandas de covers.
Continuara...

QUIET RIOT. METAL HEALTH (1984)
Súmate a nuestro Canal de Difusión en WhatsApp
RESEÑA Por Francisco Chamuco González
En el año de 1973, un joven guitarrista llamado Randall “Randy” Rhoads, quién a la postre sería el guitarrista insignia de Ozzy Osborne, y su amigo bajista Kelly Garni, decidieron formar una banda de rock junto al baterista Drew Forsyth y el vocalista Kevin DuBrow. Fue bautizada con el nombre de Mach 1.
Posteriormente, cambiaron su nombre a Little Woman y finalmente, en el año 1975 pasarían a llamarse Quiet Riot. La banda se dedicó a “picar piedra” y ganarse su respeto en el circuito de Los Ángeles, (particularmente en el área de Sunset Boulevard, donde se encuentran clubes como el Troubadour, Whisky a Go Go y el Roxy, fundamentales para la creación y desarrollo de lo que después se conocería como Glam Metal).
Como fruto de su trabajo, en 1978, consiguieron publicar en Japón su primer álbum titulado Quiet Riot, el cual tuvo, en el país del sol naciente, una modesta recepción, por decir lo menos. En 1979 regresan a Japón a grabar su segundo álbum, Quiet Riot II, el cual, al igual que su antecesor, no tuvo el éxito comercial esperado. Debido a fuertes problemas con Kevin, Garni fue a buscarlo con una pistola para matarlo, pero gracias a la intervención de que Randy llamo a la policía, fue interceptado en el camino y se logró evitar la tragedia. Como consecuencia de ello, fue expulsado de la banda y su puesto fue ocupado por el musico cubano Rodolfo Maximiliano Sarzo Lavieille Grande Ruiz Payret y Chaumont, conocido entre los compas como Rudy Sarzo.
Mientras esto sucedía, Ozzy Osbourne era despedido de Black Sabbath por su conducta errática, así como su excesivo consumo de alcohol y drogas. Sharon Arden, hija de Don Arden, Productor de Black Sabbath, vio una oportunidad de oro (literalmente) y “rescató” a Ozzy de su abismo y lo convenció de iniciar su carrera de solista. En ese contexto es que Dana Strum (Slaugther), convence a Randy Rhoads para adicionar con Ozzy. Osbourne, al escucharlo, se queda maravillado con el joven guitarrista, quién decide abandonar Quiet Riot para unirse al nuevo proyecto del ex vocalista de Black Sabbath.
La salida de Randy trajo como consecuencia una crisis dentro de la banda, cambiando nuevamente de nombre e integrantes. Ahora, de Quiet Riot, pasó a llamarse a DuBrow (ya desde ahí se iba visualizando el ego enfermizo de Kevin DuBrow).
La banda estaba conformada por Kevin en las vocales, el guitarrista de origen mexicano Carlos Cavazo, Rudy Sarzo en el bajo, y Frankie Banali en los tambores.
Llevaban mucho tiempo tocando en la escena de Los Ángeles, pero solo lograban alcanzar fama y notoriedad a nivel local, nada más allá de Sunset Boulverad. Sin embargo, su suerte estaba a punto de cambiar. Un viejo Productor llamado Spencer Proffer (quién había grabado a Tina Turner y a Paul Anka anteriormente), al ir conduciendo en su vehículo y escuchando la radio en una estación de Pop de los Ángeles, entre Roxanne de The Police y Tainted Love de Soft Cell, transmitió "Cum On Feel the Noize", una canción de Slade, banda inglesa que había tenido mediano éxito en Inglaterra, que eran unos perfectos desconocidos en Estados Unidos. La canción le pareció festiva, de unión, y pensaba que podría convertirse en un himno.
Proffer tenía un contrato con la disquera CBS y creyó (y no se equivocó el cabrón), que regrabándola y produciéndola él mismo, podría ser un éxito rotundo en Estados Unidos. Ahora solo faltaba encontrar a la banda que se encargaría de hacer el trabajo musical, por lo que, siguiendo el consejo de un amigo, fue a ver a unos desconocidos llamados DuBrow en el Country Club en Reseda, California. Quedó encantado al ver su presentación. Aquella banda tocaba macizo, estaban bien coordinados y haciendo participar al público en sus presentaciones, la cual encajaba como anillo al dedo para su proyecto.
Al término de su show, fue a presentarse ante Kevin, diciéndole que le gustó mucho su música. La banda ya tenía canciones como Bang your Head y Party All Nigth. Proffer le dijo que tenía un estudio de grabación (Pasha), ofreciéndole un trato. Si ellos se animaban a grabar un cover que él pensaba que se convertiría en un éxito, él les prestaría su estudio para que pudieran grabar sus temas propios.
En un inicio no le gustó mucho la idea a Kevin (ya que le parecía poco digno grabar y publicar una canción no escrita por el), pero después de discutirlo con sus demás compañeros, y ante el hecho de que habían sido ya rechazados por todas las disqueras habidas y por haber, decidieron aceptar la oferta de Proffer, ya que no tenían de otra. Entraron a Pasha Studios (donde posteriormente se grabaría también el Appetitte for Destruction de Guns and Roses, entre muchos otros), y grabaron en muy poco tiempo, los temas propios.
Al llegar el turno de tocar por primera vez en el estudio Cum On Feel the Noize (la cual medio la habían ensayado), Proffer quedó impactado por el resultado. Afortunadamente el ingeniero de audio grabó la pieza. Únicamente faltaba la voz de Kevin para completar el plan. A pesar de que nunca estuvo del todo de acuerdo de grabar un cover, hizo tan buen trabajo que a la primera toma quedó, según la leyenda.
Con Cum On Feel the Noize regrabado en mano (y sin mucha fe en los demás temas), Proffer decide viajar a Nueva York para visitar a sus amigos de la disquera CBS, a quienes reprodujo las grabaciones de su nueva banda, enfatizando principalmente el potencial del cover de Slade. Una vez terminada la reunión, los ejecutivos de la disquera le dijeron que era una basura lo que estaban escuchando y le pidieron que regresara cuando tuviera un proyecto mas vendible.
Frustrado, Proffer llamaó a Walter Yetnikoff, que era el presidente de CBS, a quién le dijo que, si habían firmado un contrato con él, era porque la disquera creía en su visión para identificar nuevas bandas que pudieran llegar a ser un éxito comercial, por lo que le pidió que confiara en el, y le permitiera terminar y publicar el álbum, obteniendo la aprobación de Yetnikoff, por lo que la banda regresó al estudio, y grabaron los demás temas que completarían el álbum.
Sin embargo, había un problema. A la disquera no le gustaba el nombre de DuBrow (a mucho pesar de Kevin), por lo que la banda decidió que publicarían el álbum bajo su nombre anterior, Quiet Riot.
Finalmente, Metal Health salió a la venta el 11 de marzo de 1983. El viejo Proffer no se equivocó. Desde el momento de su publicación, Cum On Feel the Noize pegó con todo. Con todo, con todo. La canción alcanzó el #1 de Billboard, convirtiendo a Quiet Riot en la primera banda de metal que alcanzó dicha posición en la lista de la música mas escuchada de la música pop.
Por primera vez el Metal había entrado al mainstream. Logró colarse dentro del gusto popular, no solamente en circuito metalero. Esto potenció enormemente el ego de Kevin, (quien un día sí y otro también declaraba que gracias a Quiet Riot, bandas como Ratt, Dokken y Wasp tuvieron éxito, entre otras mamarrachadas.)
La maqueta consta de 10 temas:
1).- Bang your Head (Metal Health). A título personal, la mejor canción del álbum y probablemente de la banda. Metal ochentero a mas no poder, con letras muy al estilo de la época. Un redoble de Banali da paso a una explosión de metal con unos gritos que anuncian de que se trata la cosa. Gran bajo, gran batería, gran guitarra y grandes voces y gritos del de los pelos chinos. Una joyita atemporal que nunca aburre.
2).- Cum on Feel de Noise. ¿Qué puedo decir de esta versión? Muy bien lograda, adaptada a la época. No la destruye, le hace justicia. Soy fan de Slade pero me gusta más esta versión. Bueno, quien sabe. Jaja.
3).- Don't Wanna Let You Go. Algo parecido a una balada que nos muestra a una banda madura, consolidada. Se escucha aún la esencia anterior de la banda, setenterona, muy, muy buena. Trata de relaciones rotas y desamor. Uyuyuyyyayayayyyy que chulada madre mía.
4).- Slick Black Cadillac. Es la única pieza en la que aparece en los créditos Randy Rohads, ya que originalmente fue publicada en el Quiet Riot II. Nos regresa al espíritu del álbum, potente y con toda esa atmosfera fiestera tan característica del género.
5).- Love's a Bitch. Una especie de power ballad pesadona que abriría la puerta a experimentar a otras bandas de glam metal en el género romanticón. Muy buena.
6).- Breathless. Heavy metal ochentero de alta manufactura. Gran pieza. Los impresionantes solos de Carlos Cavazo dan muestra de lo infravalorado que es como guitarrista. Muy bien lograda de principio a fin.
7).- Run for Cover. Rápida, potente. Con un solito cachetón de Banali, grandes solos nuevamente de mi Charly y unos gritos donde muestra musculo Kevin, es la más rápida del álbum y con un final espectacular.
8).- Battle Axe. Un gran solo de guitarra del maestro Carlos Cavazo. A pesar de que es un GRAN guitarrista y es una muy buena pieza, a título personal creo que esta fuera de lugar en el álbum. Me gusta mucho, pero creo que no encaja.
9).- Let's Get Crazy. Metal ochenterote en el que cada uno de los integrantes de la banda se luce. Sienta las bases de un estilo que fue copiado por otras bandas de la época, pero ahí si mejor no comento más detalles jajaja. Buena de principio a fin.
10).- Thunderbird. Un homenaje a su antiguo guitarrista Randy Roahds quién había fallecido en un accidente de avioneta un año antes, y del cual hablaremos en otro artículo más a detalle en el futuro. Es una buena balada, no más.
Chihuahua, la entidad metalera por antonomasia del país, no sería ajena al fenómeno que causó Quiet Riot con Metal Health. Las estaciones de la época (12.80, La Pantera y la más comprometida con el rock, El Lobo) reprodujeron hasta el cansancio Cum on Feel the Noise y Bang your Head (Metal Health).
Los que por aquellos entonces ya éramos rockersillos, escuchamos ese álbum miles de veces, y esas mismas veces lo disfrutamos. En mi caso, hasta el día de hoy.
Tuvieron que pasar muchos años para que la raza de Chihuahua pudiera verlos en vivo. El 3 de mayo de 2001, con motivo de su gira Guilty Pleasures, la banda se presentó en el Rodrigo M. Quevedo con su alineación “clásica”: Kevin DeBrow (vocales), Rudy Sarzo (Bajo), Carlos Cavazo (guitarra) y Frankie Banalli (batería). Como grupo abridor, tocó Genitallica. Craso error. Desde que inició su presentación, la gente no paró de abuchearlos y aventar objetos hacía el escenario. No justifico el comportamiento del respetable, pero creo que fue una malísima idea presentar como acto abridor, a un grupo de la llamada “avanzada regia” como telonero en un concierto de metal. Y más en Chihuahua.
Dejando de lado el cálido recibimiento que les dimos a los Genitallicos en Chihuahua, Quiet Riot, a pesar de tocar únicamente por media hora, tuvo una muuuuuuy buena presentación y la gente, aunque un poco inconforme por lo corto del evento, salió contenta. Tenían esa deuda con Chihuahua y fue saldada.
Luego de este álbum, la banda publicaría el 7 de julio de 1984 Condition Critical, un álbum mediano en el que quisieron aplicar la misma fórmula: sacar un cover de Slade. En este caso fue Mama Weer All Crazee Now, que, si bien se convirtió en un éxito y salvó al álbum de ser un fracaso, no alcanzó ni la sombra de su antecesor. ¿Lo demás? Una carrera en franco declive y hechos trágicos como la muerte de Kevin por sobredosis de cocaína en 2007, y la de Frankie Banali en 2020 por cáncer de páncreas. Se separaron y reunieron muchas veces, y pasaron tantos miembros por la banda, que en algún momento no contaba con ¡ningún miembro original! En la actualidad Rudy Sarzo es el único miembro original, al menos, de la alineación clásica.

We Wish You A Metal Xmas And A Headbanging New Year
Por: Chamuco González
WE WISH YOU A METAL XMAS AND A HEADBANGING NEW YEAR es un álbum de villancicos navideños, interpretados por músicos de la talla de Lemmy Kilmister, Alice Cooper, Tommi Iommi, Michael Schenker, Dio, y Dave Grohl, entre muchos otros. Trabajo muy bien logrado, y especial para celebrar en estas fiestas decembrinas. Ampliamente recomendado. Feliz Navidad y próximo Año Nuevo!

Pantera - Vulgar Display of Power
Por: Chamuco González.
A principios de los años noventa, el metal vivió una crisis tal, que casi lo lleva a la extinción. Muchas bandas dejaron de sacar discos y de los pocos que se publicaron, la mayoría fueron muy malos. (No menciono ejemplos para no herir susceptibilidades).
La realidad de las cosas es que el cambio de década agarro mal paradas a las bandas y el metal se vino abajo. Los medios y la gente tenían puesta su atención en nuevas bandas como Pearl Jam, Nirvana, Soundgarden, Stone Temple Pilots, entre otras, las cuales tocaban Grunge, un nuevo género que había llegado con mucha fuerza y amenazaba con enterrar de una vez por todas a nuestro amado metal. El que lo niegue, o no era rockero en aquellos ayeres, o peca de necedad.
En ese contexto de aridez y apatía, el 25 de febrero de 1992 se publica un álbum que vendría a reivindicar y aportar nuevos bríos al metal. Vulgar Display of Power (título sacado de la hermosa película El Exorcista), es el sexto álbum de la banda tejana, la cual, apenas empezaba a darse a conocer a nivel mundial.
Antes de abordar el Vulgar Display of Power, es importante mencionar, al menos de paso, sus trabajos anteriores para comprender la evolución de su sonido.
Sus primeros cuatro trabajos, a pesar de que pasaron sin pena ni gloria, no son malos. Metal Magic (1983), Projects in the Jungle (1984) y I Am the Night (1985), son álbumes con un cargado sonido de Glam y Heavy Metal con cierta influencia de Kiss. Todos ellos fueron producidos por el padre de Vinnie Paul y Diamond Darrell, Jerry Abbott (un compositor y productor de música country, propietario de un estudio de grabación llamado Pantego Sound Studio en Arlington, Texas).
La alineación hasta ese entonces la conformaban Terry Glaze en las vocales, Rex Brown en el bajo, y quienes eran el alma de la banda, los hermanos Abbott, Vinnie Paul en la batería y Diamond Darrell en la guitarra.
En 1989 sale de la banda Terry Glaze y entra en las vocales Phil Anselmo. Publican Power Metal, un álbum que ya no suena glamero sino más pesado, algo parecido a una mezcla de Speed con Heavy Metal. Muy buen disco en mi opinión.
Para 1990 y bajo la producción de Terry Date (quién había trabajado ya con Metal Church), publican Cowboys from Hell y a partir de ahí es cuando realmente empiezan a sonar a Pantera. Un discazo del cual no hablaré mucho ya que merece una reseña aparte.
En la gira de promoción del Cowboys, telonearon para bandas como Skid Row, Megadeth y Judas Priest. A su regreso, entran nuevamente al estudio de su padre e inician el proceso de grabación de Vulgar Display of Power, actividad que debieron suspender al poco tiempo ya que fueron invitados a participar en el legendario festival Monsters of Rock en Moscú, donde tocaron ante cientos de miles de personas al lado de AC/DC, Metallica y Black Crowes. Algo que jamás se abrían imaginado estaba empezando a darse.
Desde el momento en el que Vulgar Display of Power fue publicado su impacto fue inmediato. Escuchar el álbum por primera vez (en ese contexto y en aquel tiempo), era algo similar a su portada, un puñetazo en la cara. Era música menos rápida que el Speed y el Trash, pero con más potencia y mucha más agresividad. Era algo nuevo llamado Groove Metal. (Prong, Exhorder).
La maqueta consta de 13 temas. Mouth for War, A New Level, Walk (el tema más famoso de la banda), Fucking Hostile, This Love, Rise, No Good, Living in a Hole, Regular People, By Demons be Driven y Hollow.
Phil Anselmo se devela como un compositor obscuro, crudo, que sabe plasmar bien en sus letras el dolor, la rabia y la frustración de quién vive atrapado en batallas con sus demonios internos. La rudeza y agresividad que transmiten sus gritos es única.
La guitarra de Diamond Darrell por su parte, tiene tanta presencia que pareciera que puedes tocarla. Sus riffs y sus armónicos son como huellas digitales que solo con escucharlos, sabes que se trata de él. Sus solos, rápidos, precisos, geniales.
Algo parecido pasa con su hermano Vinnie, su forma de tocar el doble bombo, así como sus contratiempos, lo hacen fácilmente reconocible para cualquier metalero de medio pelo.
Rex Brown hace un muy buen trabajo en la base rítmica y tiene arreglos que encajan a la perfección.
Con respecto a la portada, durante mucho tiempo existió el mito de que, para lograr la icónica imagen del álbum, habían pagado a un tipo en la calle la cantidad de 10 dólares por dejarse golpear, logrando capturar la imagen del momento exacto del impacto. Nada más falso. En el año 2012, el fotógrafo Brad Guice declaró a la revista Revolver que la fotografía se tomó en su estudio bajo una simulación y efectos.
Vulgar Display of Power fue sin lugar a dudas el álbum que consagró la carrera de Pantera, ubicándolos desde ese momento en un lugar al lado de las mejores bandas de metal de todos los tiempos e influenciando a bandas como Lamb of God, White Zombie, Five Finger Death Punch y Slipknot, entre otras. Si no ha escuchado este disco alguna vez, no se vaya a morir antes de hacerlo. Hágame caso, no se arrepentirá.

¿Disco nuevo de los Sex Pistols?
Por: Francisco Chamuco González
Debo de confesar que, de unos años para acá, he dejado de escuchar música en formato físico para hacerlo en formato digital. Es vergonzoso, pero así es. El Nevermind The Bullocks Here´s the Sex Pistols (1977) es uno de esos discos que, a pesar de que lo escucho desde mis primeros años de adolescencia, no me aburre y de vez en vez, lo sigo escuchando. No tiene una canción de relleno, todas son excelentes.
Quise escucharlo una noche y en lugar de reproducir una copia de la primera prensa inglesa de 1977 en vinilo, busqué en youtube “Sex Pistols”. Es penoso, pero así fue. Seguramente me saldrían videos de pantalla amarilla, el color de la portada del único álbum de estudio de la banda, pero no, obtuve como resultado de dicha consulta varios videos de unas presentaciones recientes.
No sabía que se habían reunido. Me sorprendió muchísimo que dicha reunión era sin el Maestro John Lydon (Johnny Rotten para los compas). QUEEE???
Como todo genio, la personalidad de Rotten no es fácil. Aunque con sus fans tiene fama de ser sencillo y muy accesible, con los demás miembros de la banda supuestamente es insoportable. Nomás no está peleado con Sid Vicious porque está muerto, ya que todos los demás no llevan buena relación con él. Esta loco.
La última de sus peleas se debió a que Netflix publicó en 2022 una miniserie llamada Pistol, basada en un libro autobiográfico de Paul Jones (guitarrista de la banda) titulado 'Lonely Boy: Tales From A Sex Pistol' y a Johnny Rotten no le gustó que usaran su música, y los demandó. Y también perdió.
Desde la disolución del grupo, Jhonny Rotten formó PIL (Públic Image Limited), y desde 1978 hasta la fecha, han publicado 16 discos. Bandota. El resto de los Sex Pistols, salvo las pocas presentaciones que tuvieron con con Rotten, y algunos trabajos sin mayor relevancia, no han hecho nada desde 1977.
Volviendo a la reunión, la banda actualmente está conformada por los 3 originales: Steve Jones (guitarrista), Paul Cook (batería) y el gran bajista Glen Matlock. Las vocales corren a cargo de un tipo llamado Frank Carter.
Cantó con Gallows, Pure Love, y su última banda llamada Frank Carter and the Rattlesnakes. La verdad cumple y cumple más que bien. Hace ciertos guiños a Rotten en sus movimientos y en alargar los gritos de la forma que solo Johnny sabe hacerlo. Tocaron los 12 temas del Nevermind y ahí entreverada se aventaron No Fun de los Stooges.
Carter no busca copiar a nadie (como el enano filipino aquel que suplantó a Steve Perry en Journey).
De los Pistols que se puede decir, nomás no rajan leña los viejitos. Potentes, sólidos, integrados.
Este Frank sí que tiene voz propia, presencia escénica y la actitud necesaria para cantar en una banda de punk de primera línea. Sin embargo, a título personal creo que Sex Pistols sin Johnny Rotten no son los Sex Pistols.
Carter es como un medicamento similar, es lo mismo, pero más barato.
La reunión de la banda se dio supuestamente para apoyar económicamente al famoso foro Bush Hall de Londres los días 13 y 14 de agosto, el cual atraviesa serios problemas financieros que ponen en riesgo su funcionamiento.
Lo que inició como 2 fechas de beneficencia, hoy son ya son varias fechas confirmadas en el Reino Unido y España. Parece ser el inicio de una gira mundial y no es para menos.
Los Rattlesnakes ya anunciaron una pausa indefinida, o sea, que ya los desafanó Carter. Todo indica a que no solo saldrán de gira. Creo que grabarán nuevo material. Y al hacerlo, podrían de alguna forma en riesgo su legado. Si no pregúntenle a Pink Floyd por su último disco.
Aunque Carter dé un aire fresco a la banda y haga los aportes necesarios, tienen la vara muy, pero muy alta.
El único álbum de estudio de la banda Nevermind The Bollocks Here´s The Sex Pistols me parece un álbum imposible de superar y Johnny Rotten un vocalista irremplazable. Sin embargo, a pesar de todo lo anterior, me encantaría escuchar un disco nuevo de los Sex Pistols. Estoy seguro que, de darse, será un gran álbum.

RUSH. 2112 (1976). RESEÑA
Por: Chamuco González
Bajo la amenaza de cancelar su contrato discográfico debido a las bajas ventas de su álbum anterior (Caress of Steel), su Manager, Ray Danniels, haciendo uso de sus buenos oficios, logró conseguir una última oportunidad. Grabarían un disco más, con la condición por parte de la compañía, de hacer un disco con música menos compleja, menos elaborada. Debían publicar algo más comercial, temas de corta duración. Vaya, buscaban que la banda consiguiera uno o varios hits en la radio.
Ante ello, Geddy Lee, Alex Lifeson, y Neil Peart, decidieron hacer lo que consideraron correcto. No claudicarían ante la presión de la industria musical y decidieron sacar un disco majestuoso, a su gusto, no al de los demás y mucho menos al de la industria musical. No se venderían jamás, y si ese último disco representaba el fin de su carrera musical, aceptarían ese final con gallardía y dignidad.
Podrían llevar la cara en alto por no haberse traicionado a sí mismos. Compusieron, grabaron, masterizaron, fabricaron y publicaron 2112 en solo 6 meses después de la publicación del Caress of Steel. Mucho más que un tiempo record. Una locura. No hubo problema, la tercia daba para eso y para más.
En ese contexto, el álbum vio la luz el 1 de abril de 1976. La obra (ciencia ficción), es una distopía que nos recuerda 1984 de George Orwell, así como Un mundo Felíz de Aldous Huxley, entre otros clásicos.
Inspirada en la obra Himno de la escritora rusa Ayn Rand (quién escapó de las atrocidades de la Rusia zarista a finales de los años treintas), 2112 se desarrolla en un planeta sometido por un régimen totalitario en el que sus habitantes ven, escuchan, piensan y hacen únicamente lo que se les ordena. Cualquier libertad o derecho es inexistente. Una imagen tan antigua y tan actual al mismo tiempo, que el álbum cobra relevancia y vigencia hasta nuestros días.
Dividido 2 partes, el Lado A del álbum contiene 2112, una suite conceptual (todos los temas están relacionados con la misma historia) de 20:22 minutos dividida en 7 partes. El lado B, contiene 5 temas que, aunque nada tienen que ver con la historia del Lado A, son grandes canciones.
En la contraportada del álbum, justo debajo de la fotografía de los tres chiflados (vestidos con sendas túnica galácticas), aparece un texto firmado por Anonymous o Starman (el protagonista de la historia), con el que da inicio esta joya musical:
Lado A
2112
“Me quedo despierto, mirando la desolación de la ciudad de Megadon. Ciudad y cielo se vuelven uno, fusionándose en un solo plano, un vasto mar de gris ininterrumpido.
Las dos lunas, solo dos pálidas orbes mientras trazan su camino a través del cielo de acero.
Solía pensar que tenía una vida bastante buena aquí, simplemente conectándome a mi maquina durante todo el día, luego ver Templovisión o leer un Temploperiódico por la noche.
Mi amigo Jon siempre decía que era mejor aquí que bajo las cúpulas atmosféricas de los Planetas Exteriores. Hemos tenido paz desde 2062, cuando los planetas sobrevivientes se unieron bajo la Estrella Roja de la Federación Solar. Los menos afortunados nos dieron unas cuantas lunas nuevas.
Creía lo que me decían. Pensaba que era una buena vida, pensaba que era feliz. Luego encontré algo que lo cambio todo..”
Anonymous. 2012
I.- Overtura
Unos sonidos espaciales nos dan la bienvenida, como diciendo, “abróchense los cinturones”. Al terminar la sonorización futurista, explota la canción con un hard rock-progresivo que anuncia la calidad de lo que está por venir. Desde esta primera parte de la suite, la banda nos muestra el nivel y la intención de la obra. Potencia y elegancia pura. Sin más. Al final, se escucha una explosión y un profético “And the meek shall inherit the earth (y los mansos heredarán la tierra)”.
II.- Temples of Syrinx
Siguiendo la misma línea musical de la parte anterior, los Sacerdotes del Templo de Syrinx hablan de su dominio sobre los habitantes del planeta, a quienes despojaron de toda libertad e individualismo. Con grandes computadoras dentro de las paredes del Templo, controlan todos y cada uno de los aspectos en la vida de las personas. Son los nuevos dueños del planeta.
III.- Discovery
Anonymous ó Starman, el protagonista, descubre un objeto nunca antes visto por él. Dice que cuando lo toca, emite un sonido. Tiene cables, y éstos, al tocarlos, producen música. Es una guitarra. Extasiado, decide ir con los Sacerdotes del Templo de Syrinx para mostrarles su descubrimiento y poder así, compartir esa maravilla con los demás habitantes del planeta. Lifeson reproduce magistralmente la escena al tocar apenas las cuerdas en un inicio, afinar, y poco a poco empezar con pequeños acordes hasta llegar a ejecutar el instrumento con gran maestría.
IV.- Presentation
Al acudir ante los opresores, Starman les muestra lo que les dice, es un milagro antiguo. Éstos lo reprenden duramente ordenándole que se deje de tonterías, le dicen que ya conocen el aparato, el cual fue causante de la catástrofe de los anteriores habitantes del planeta, según le dicen.. Además, éste no encaja en el plan. El mundo funciona bien así, según ellos. Anonymous protesta diciendo que no puede ser verdad lo que está escuchando. El mundo debe conocer esta belleza, insiste. Los Sacerdotes aseguran estar muy ocupados y le piden olvidar caprichos tontos. Debes pensar como la mayoría, le ordenan. Musicalmente la banda describe muy bien, primero, la falta de comprensión por la inocencia de Anonymous, y segundo, la frustración que siente al no poder compartir con los demás su reciente descubrimiento. Pasa de la calma a la furia con un final en el que Alex Lifeson nos regala un solo de guitarra extraordinario queen momentos nos recuerda al de Free Bird de Lynyrd Skynyrd.
V.- Oracle: The Dream
Nuestro protagonista, al ir caminando, cae en un extraño sueño. De pronto, se ve frente a un óraculo. Le pide que le muestre la verdad y el oráculo le enseña cómo era la vida en el planeta antes de estar bajo el yugo de la Estrella Roja de la Federación Solar. Ve ante sí, un mundo de conocimiento y de progreso. De libertad. Ve también que a pesar de que los antiguos habitantes debieron abandonar el planeta, tienen un plan para recuperar su antiguo hogar. El principio de la caída del Templo de Syrinx..
VI.- Soliloquy
Tanto la letra como la música, expresan a la perfección la catarsis y el dolor por el que atraviesa Starman, el cual, al tener conciencia de la vida anterior que había en el planeta, le es ya imposible seguir viviendo bajo la opresión de la Federación Solar, por lo que decide quitarse la vida con la esperanza de pasar al mundo visto en su sueño.
VII.- Gran Finale
Como su nombre lo dice, esta majestuosa pieza sirve para cerrar la suite con una explosión de rock progresivo en que la banda emula musicalmente una última batalla en el planeta, mediante la cual, los antiguos habitantes del planeta derrocan a los opresores de la Federación Solar para recuperar su hogar. Justo antes de terminar la pieza, se escucha una voz robótica anunciando la caída de la Federación: ATENCIÓN A TODOS LOS PLANETAS DE LA FEDERACIÓN SOLAR: HEMOS ASUMIDO EL CONTROL. Esta pieza es cierre épico. Rápida, potente. Espectacular.
Lado B
Passage to Bangkok
Trata acerca de un viaje a alrededor del mundo en el que los miembros de la banda visitan lugares emblemáticos por la calidad de su hierba de olor. Bogotá, Jamaica, Nepal, Marruecos, Líbano, y Afganistán aparecen en su ruta. Y como mi México querido no podía quedar fuera de la lista, le dedicaron la línea “..Acapulco Golden Nights”. Fume y fume. Risa y risa. Gran canción.
Twilight Zone
Inspirada en dos capítulos de la serie televisiva de misterio de los años 60´s (bautizada en México como La dimensión desconocida), es una canción tranquila con letras abstractas. Rockcito setentero de tejido fino muy en la onda de la serie. Bien lograda, me gusta mucho. Nainainainainaiii canta Don Geddy. El solo de Lifeson es hermoso. Me encanta.
Lessons.
Una compasión solista de Alex Lifeson que nos habla sobre las lecciones que nos da la vida y la consecuencia en la toma decisiones. Una canción tranquila, que se transforma en un hard rock sólido. Destacables las vocales de Geddy y la guitarra de Lifeson. Una chulada
Tears
Una canción fuera de lugar. Guitarras limpias, tristes. Una letra simplona que nomás no acabo de entender. No me gusta. No encaja para nada en la tónica ni en la vibra del disco. No sé si la incluyeron como relleno (lo dudo mucho), pero definitivamente se trata del prietito en el arroz.
Something for Nothing
Letra inspirada en un grafiti que Neil Peart vio en Los Angeles, la pieza cierra de formal inmejorable el álbum. Hard rock que nos recuerda su primer álbum. Un cierre perfecto.
Comentario final:
Este álbum catapultó a la banda a nivel mundial y representó un éxito en todos los sentidos. Revolucionó al rock progresivo (estábamos acostumbrados a bandas como Génesis, Emerson Lake and Palmer, Yes, King Crimson y llegaron éstos, más rápidos, más rockeros, más todo.. ai perdón).
La aportación más grande de Canadá para el mundo acaba de despegar sin intención de detenerse.
Vendrían mas adelante una larga lista de discos excepcionales que hicieron de Rush, una de las vacas sagradas del rocanrol de todos los tiempos. Puntuación: 9/10.


















